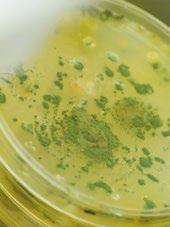

LIBERANDO EL POTENCIAL DEL SORGO
EN LA ALIMENTACIÓN DE AVES DE CORRAL Y CERDOS

![]()


La nutrición animal está en constante evolución, impulsada por la necesidad de adaptarse a desafíos globales como el cambio climático, la escasez de recursos y las crecientes exigencias productivas. Por lo que, la resiliencia y la capacidad de aprovechar al máximo los recursos disponibles serán fundamentales para enfrentar los desafíos futuros, asegurando que la nutrición siga siendo un motor de productividad y bienestar en un mundo en constante transformación.
En esta edición, encontramos un par de contenidos acerca de la utilización del sorgo en nutrición animal.
Dicho cultivo, resistente y adaptable, busca ganar terreno en la formulación de dietas de especies de interés ganadero. La exploración de nuevos niveles de inclusión abre un abanico de posibilidades, así como también de interrogantes.
Justamente es esta exploración, la que permite al sector comportarse de manera versátil frente a escenarios muy dinámicos.
El estudio de nuevas materias primas, no debería opacar la sed de mayores conocimientos de aquellas a las que podríamos llamar tradicionales. Volver a las bases, a veces es una excelente opción.
Por eso y mucho más, los invito a leer esta edición, donde exploramos estos y otros temas que reflejan cómo la innovación en la alimentación animal permite optimizar el rendimiento y la salud, desde la producción avícola y porcina hasta la nutrición de mascotas.
¡Que aproveches la lectura! Dr. Bernardo F. Iglesias
EDITOR
GRUPO DE COMUNICACIÓN AGRINEWS S.L.
PUBLICIDAD
Simone Dias +55 11 985852436 nutribr@grupoagrinews.com
Luis Carrasco +34 605 09 05 13 lc@agrinews.es
Victoria Domingues +55 41 992091549 nutrisocial@grupoagrinews.com
DIRECCIÓN TÉCNICA
Bernardo Fabricio Iglesias
Cecilia Cajarville
Juan Gabriel Espino
COORDINACIÓN TÉCNICA
Facundo Apecetche
REDACCIÓN
Amanda Abalo
Daniela Morales
Facundo Apecetche
Osmayra Cabrera
COLABORADORES
Carlos De Blas (UPM)
Gonzalo Glez. Mateos (UPM)
Xavier Mora (Consultor)
Alba Cerisuelo (CITA-IVIA)
Carlos Fernández (UPV)

Luis Miguel Gómez Osorio (CES)
Edgar Oviedo-Rondón (USSEC)
ADMINISTRACIÓN
Merce Soler
Tel: +34 677518854 admin@agrinews.es
www.nutrinews.com
Precio de suscripción anual: 90 USD
ISSN (Revista impresa) 2696-810X
ISSN (Revista digital) 2696-8118
GRATUITA PARA FABRICANTES DE ALIMENTO BALANCEADO, EMPRESAS DE PREMIXES Y NUTRICIONISTAS
Depósito Legal Nutrinews B-17990-2015

Liberando el potencial del sorgo en la alimentación de aves de corral y cerdos




; Alana B. ; Vivian I. Vieira1*; Simone G. de Oliveira3*
1Programa de Postgrado en Zootecnia (PPGZ)
2Programa de Postgrado en Ciencias Veterinarias

Observando a las micotoxinas: cómo pueden impactar y bajo qué condiciones (caso práctico) 32
Ing. Químico Bessone Patricio Departamento técnico comercial Avícola – CLADAN SA Nutrición y Salud Animal Actualización
Eficacia in vitro de PeptaSan™

Actualización

El agua, el nutriente más importante en nutrición porcina
Juan Gabriel Espino
Nutricionista especialista en monogástricos
Suplementación de lisina al final de la gestación para estimular el desarrollo mamario de cerdas primerizas 50 59 62

La suplementación con CELMANAX en dietas de cerdas y lechones en el criadero mejoró el rendimiento de las cerdas y los cerdos de engorde en un ensayo de investigación comercial
S. Jalukar1 , C. Rippe, and S. Fribourg2
1Arm & Hammer Animal Nutrition, Princeton, NJ
2Adisens, Peru

66
Chantal Farmer
Agriculture and Agri-Food Canada, Sherbrooke Research and Development Centre, Sherbrooke, Québec, Canada

Arm & Hammer: Conocimientos globales sobre producción animal aplicados localmente a granjas latinoamericanas
Guilherme Minozzo yJesús Mejia Arm & Hammer Animal Nutrition.
El sorgo, un grano que prospera en tiempos de cambio climático (Parte II)

Cecilia Cajarville, José Luis Repetto
Departamento Producción Animal y Salud de Sistemas Productivos - IPAV, Facultad de Veterinaria, UdelaR, San José, Uruguay.
Controlar el consumo residual de alimentos es mantener el equilibrio (Parte II)

Fernando Bacha Baz Director técnico en Nacoop
Minerales en el alimento de perros y gatos: efectos de la extrusión y vida útil



Ingrid Caroline da Silva1 , Karla Gabriela Memare 2 , Bruna Aparecida Moreira da Silva2
1Doctorada en Producción Animal - UEM
2Licenciada en Zootecnia - UEM

Ana C. B.Doi1*; Alana B. Serraglio2*; Vivian I. Vieira1*; Simone G. de Oliveira3* 1Programa de Postgrado en Zootecnia (PPGZ); 2Programa de Postgrado en Ciencias Veterinarias (PPGCV); 3Profesor Adjunto; *Universidad Federal de Paraná, Curitiba/PR

A escala mundial, según el USDA (2024), Estados Unidos lidera el ranking de producción de sorgo (Sorghum bicolor L. Moench) con 8.071 millones de toneladas, seguido de Nigeria y Sudán.




Originario de África, el sorgo es reconocido por sus propiedades nutricionales, destacándose por su notable adaptabilidad a condiciones climáticas y edáficas adversas, mayor tolerancia al estrés hídrico, alto valor energético y versatilidad como ingrediente en la alimentación de animales de producción (Nunes, 2005; Carvalho, 2010).
Sin embargo, su inclusión requiere un análisis cuidadoso de las variaciones en su composición, especialmente en relación con la gran cantidad de taninos y factores antinutricionales, que pueden impactar negativamente en la digestibilidad y el rendimiento animal (Selle et al., 2018).
En términos nutricionales, se recomienda a niveles prácticos utilizar 30% de sorgo en dietas para pollos de engorde en la fase inicial y ponedoras, y 35% en dietas para cerdos en la fase de acabado.

Existen diversas variedades de sorgo, como el sorgo forrajero, el sorgo azucarero, el sorgo de escoba, el sorgo de biomasa y el sorgo granífero, que se utilizan para alimentar a los animales monogástricos.
El sorgo granífero es un tipo de sorgo de bajo crecimiento que produce una panícula en el extremo superior, donde se encuentran los granos. Los cultivares de sorgo granífero difieren en términos de rendimiento de grano, tolerancia a enfermedades, ciclo vegetativo y otras características agronómicas (Melo et al., 2023).
El grano de sorgo presenta una amplia gama de tonalidades, siendo las más frecuentes el blanco, el bronce y el gris. Aunque los granos son generalmente esféricos, su tamaño y forma pueden variar (Nunes, 2000)
Se compone de tres partes principales: el pericarpio, el endospermo y el germen (Figura 1). La proporción relativa de estos componentes en el grano varía, pero en la mayoría de los casos es del 6%, 84% y 10%, respectivamente (Pereira Filho e Rodrigues., 2015).
Pericarpo

Escutelo
Caulículo
Gérmen
Testa
Endosperma vítreo
Endosperma farináceo

Figura 1. Estructura del grano de sorgo. Fuente: Adaptado de Nunes (2000).
El pericarpio está formado por tres capas: epicarpio, mesocarpio y endocarpio, y justo debajo se encuentra el tegumento, la estructura donde se localizan los taninos.
El germen está formado por dos tejidos, el caulículo y el escutelo, que contienen lípidos, proteínas, enzimas y minerales.
Alrededor del 88% de los gránulos de almidón y el 80% de las proteínas se encuentran en el endospermo, que es harinoso y vidrioso (Scramin, 2013; Pereira Filho e Rodrigues., 2015).
Además, en el mesocarpio también se depositan gránulos de almidón, lo que explica el alto contenido en almidón de este cereal (Nunes, 2000).
El sorgo es un cereal similar al maíz, aunque existen diferencias en sus perfiles nutricionales (Gomes, 2020), este cereal presenta una gran variabilidad genética y en su composición bromatológica, como se puede observar en la Tabla 1

Fuente: ¹ Rostagno et al., (2017); ² Martino et al., (2012); ³ Antunes et al., (2007); 4 López y Stumpf Junior, (2000).


Como cereal energético, el almidón contenido en el sorgo representa la mayor parte del grano, donde el 70-80% está formado por cadenas de amilopectina y el 20-30% por cadenas de amilosa. En promedio, el sorgo contiene 3% de extracto etéreo, 12% de fibra y 78% de nutrientes digestibles totales (Martino et al., 2012; Pereira Filho e Rodrigues., 2015).
En términos de valores de utilización de energía, el grano de sorgo tiene 3.204 kcal/kg de energía metabolizable para aves de corral y 3.358 kcal/ kg para cerdos, en comparación con el maíz, que tiene 3.364 kcal/kg y 3.360 kcal/kg, según lo informado por Rostagno et al. (2017).
Esto demuestra que el sorgo es realmente un ingrediente con potencial energético para sustituir al maíz.
Del contenido proteico del grano, estas proteínas se encuentran en mayor cantidad y se almacenan dentro de cuerpos proteicos que contribuyen a su estabilidad y protección.

La porción de endospermo vítreo del sorgo es más gruesa en comparación con el endospermo harinoso, que se compone principalmente de proteínas y polisacáridos no amiláceos, y se caracteriza por ser denso, duro y resistente a la penetración del agua y a la actividad enzimática (Sapaterro et al., 2011).
Al igual que las zeínas del maíz, el sorgo tiene kafirinas, que son prolaminas, un grupo de proteínas de reserva.
Sin embargo, esta protección puede obstaculizar la acción de las enzimas digestivas, reduciendo la digestibilidad de las proteínas (Belton et al., 2006). Además, las kafirinas forman enlaces disulfuro intra e intermoleculares que dificultan su ruptura (Abdelbost et al., 2023).


La figura 2 muestra una caracterización del endospermo del grano de sorgo, de modo que es posible identificar la disposición de los gránulos de almidón rodeados de prolaminas, más concretamente de kafirinas.

A pesar de la importancia nutricional del sorgo en la alimentación animal, la presencia de componentes antinutricionales en el grano puede afectar negativamente a la digestibilidad y absorción de nutrientes, influyendo directamente en el rendimiento y la salud de los animales.
Estos compuestos desempeñan un papel defensivo de la planta frente a aves y patógenos, ya que no existe una protección física de las semillas, a diferencia de la cáscara del maíz, por ejemplo. (Magalhães et al., 2001).
A diferencia de los beneficios que estos compuestos proporcionan durante el desarrollo de la planta, cuando se ofrecen en dietas para animales monogástricos, pueden comprometer la digestibilidad, impidiendo que el animal exprese todo su potencial zootécnico.

Los principales factores antinutricionales encontrados en el grano de sorgo son compuestos fenólicos como tanino y fitato, glucósidos cianogénicos y flavonoides (Marques et al., 2007; Lima Júnior et al., 2010; Selle et al., 2018).

Está claro que las plantas absorben los nutrientes minerales del suelo y los transmiten al grano. Sin embargo, la forma en que se almacenan estos nutrientes a menudo hace que no puedan ser absorbidos por animales que no producen enzimas específicas para romper los enlaces presentes en las macromoléculas de estos compuestos.

Este es el caso del fósforo, que en las plantas se almacena en forma de ácido fítico, también conocido como fitato. La cantidad de fósforo total en la semilla de sorgo es de 4,03 g/kg, de los cuales 3,26 g/kg están complejados con fitato.

Además, el ácido fítico puede impedir la digestión al unirse directa o indirectamente a proteínas, almidón y minerales como calcio, hierro, zinc y cobre (Rooney e Pflugfelder, 1986; Liu et al., 2013; Selle et al., 2018) (Figura 3).
Figura 3. Estructura de un fitato complejado con iones de calcio (C6H6Ca6O24P6). Fuente: https://pubchem.ncbi.nlm.nih.gov/ compound/24495
Los taninos son compuestos fenólicos que pueden interactuar y formar complejos con las proteínas de reserva del grano de sorgo. Este compuesto puede dividirse en dos categorías: solubles en agua y condensados.
De ellos, los condensados son los más prevalentes y desempeñan un papel importante en la baja digestibilidad del sorgo (Scramin, 2013). Para los animales monogástricos, los taninos tienen efectos negativos, ya que forman complejos con las proteínas, causando una reducción en la palatabilidad y digestibilidad del grano (Pereira Filho e Rodrigues., 2015).
Los granos de sorgo suelen estar contaminados por diversos hongos, lo que provoca importantes pérdidas en los ámbitos sanitario, físico y nutricional.
En el proceso de deterioro de estos granos, estos hongos tienen la capacidad de provocar la degradación de componentes cruciales como proteínas, azúcares y carbohidratos.
Entre las micotoxinas más importantes que pueden contaminar los granos de sorgo se encuentran las aflatoxinas, la zearalenona, las fumonisinas y la toxina T-2 (Iamanaka et al., 2010).
Es necesario reconocer que la presencia y la concentración de las sustancias mencionadas pueden variar significativamente entre las variedades de sorgo y las condiciones de cultivo a las que se ha sometido la planta.
Los procedimientos de procesamiento adecuados, como el almacenamiento y la molienda del grano, tienen el potencial de ayudar a reducir la presencia de algunas de estas toxinas, promoviendo así la calidad y la seguridad que requiere la nutrición animal brasileña.


Es evidente que la oscilación de los precios del maíz se traduce en aumentos considerables de los costes de producción para los sectores dependientes del cereal.
En este contexto, una opción es cambiar a materias primas alternativas, como el sorgo, que puede llegar a sustituir parcialmente al maíz (Parreira Filho et al., 2020).
El sorgo ceroso híbrido se caracteriza por tener 100% de amilopectina en su composición de almidón (Zardo e Lima, 1999). Además, ya existen en el mercado variedades sin taninos ni compuestos fenólicos.
En dietas para aves y cerdos, sólo se puede considerar la sustitución total del maíz por la variedad de sorgo sin taninos.
El valor nutricional del grano de sorgo es significativo, comparable al del maíz, por lo que se acepta el uso del sorgo como sustituto del maíz en dietas para ponedoras, pollos de engorde y cerdos (Fernandes et al., 2014).

Las cepas híbridas han mejorado la composición de almidón del sorgo, lo que se traduce en mejoras en la digestibilidad del grano
Sin embargo, es necesario considerar las diferencias estructurales en los enlaces entre las fuentes de carbohidratos y proteínas, así como el almacenamiento de estos complejos en el grano de sorgo.

La sustitución del maíz por el grano de sorgo podría ser una alternativa prometedora para los monogástricos.


Cerdas primíparas, durante las fases de lactación y post-destete, alimentadas con dietas con sorgo y maíz, presentaron desempeño similar a las alimentadas con maíz solo, indicando que la sustitución parcial del grano es viable para la producción (Moreira et al., 2013).
Por otro lado, estudios con lechones y machos castrados han demostrado que el sorgo puede sustituir al maíz hasta en un 100% en las raciones sin perjudicar el rendimiento animal ni la digestibilidad de los nutrientes (Fernandes et al., 2014).
Asimismo, esta sustitución puede llevarse a cabo sin causar impactos negativos en las características de rendimiento de las aves, el rendimiento en canal de los pollos de engorde y la calidad de los huevos de las gallinas ponedoras (Assuena et al., 2008; Rocha et al., 2008).
Es importante destacar que, al igual que otros granos, para ser utilizado en la nutrición de aves y cerdos, se requieren ciertas especificaciones, como un contenido de humedad del 13%, 3% de fibra cruda, 1,5% de materia mineral y hasta 20 ppm de aflatoxina. Además, debe tener un valor mínimo de 7% de proteína bruta y 2% de extracto etéreo (Compêndio, 2017).
La digestibilidad del sorgo puede variar en función de una serie de factores, como la variedad de sorgo, el procesado, la presencia de otros componentes en la dieta y a qué animal va destinada la dieta.
En general, se sabe que el sorgo tiene una menor digestibilidad de las proteínas en comparación con otros cereales como el trigo, el arroz y el maíz. Esto se debe en parte a la presencia de factores antinutricionales, que pueden afectar a la digestibilidad de las proteínas y otros nutrientes (Marques et al., 2007).
Además, la baja digestibilidad de las kafirinas también puede contribuir a la baja digestibilidad (Belton et al., 2006)
Otro factor que puede influir es la distribución de las proteínas que rodean los gránulos de almidón en el endospermo (Sapaterro et al., 2011). En el endospermo harinoso, hay gránulos más grandes rodeados por una matriz proteica discontinua con una menor cantidad de proteínas.


En el endospermo vítreo, los gránulos son más pequeños y la matriz es más continua (Paes, 2006). La caracterización de las proteínas del sorgo puede dificultar el acceso a los gránulos de almidón y, por lo tanto, reducir su digestibilidad.
Es importante señalar que la digestibilidad del sorgo puede optimizarse mediante procedimientos de procesamiento como la molienda y los tratamientos térmicos.
La reducción del diámetro de las partículas resultante de la molienda tiene un impacto positivo en la digestibilidad de los nutrientes y en el rendimiento animal (Leandro et al., 2001).
La cocción, por ejemplo, puede mejorar la digestibilidad de las proteínas del sorgo mediante la inactivación de los factores anticalidad, promoviendo la descomposición del cuerpo proteico y mejorando la solubilidad de la proteína (Nunes, 2000; Margier et al., 2018), así como mejorar la digestibilidad del almidón mediante la gelatinización del gránulo.
La suplementación de las dietas que contienen sorgo con enzimas también es una herramienta para mejorar la digestibilidad de los nutrientes en la dieta (Leite et al., 2011) y mitigar los efectos de los compuestos presentes en el grano (Zanella, 1999; Barbosa et al., 2008).
El uso de xilanasas, celulasas y glucanasas puede mejorar la digestión del grano y también mejorar el rendimiento zootécnico de los animales, como la conversión alimenticia en pollos de engorde en la fase inicial de cría (Leite et al., 2011). Además, se han desarrollado granos híbridos para aumentar la digestibilidad de los nutrientes (Marques, 2007).



Este material ha explorado algunos puntos relacionados con el uso del sorgo en la alimentación animal, desde sus características morfológicas y composición nutricional hasta su digestibilidad y uso en monogástricos.

Al examinar la digestibilidad del sorgo, es posible comprender su viabilidad como fuente de energía y nutrientes para cerdos y aves de corral.
Además, el uso del sorgo en la alimentación animal revela ventajas económicas y medioambientales, ofreciendo una alternativa rentable al maíz, especialmente en regiones donde su cultivo puede resultar complicado.
Sin embargo, es crucial tener en cuenta los factores de mala calidad y las toxinas presentes en el grano, que pueden repercutir negativamente en la salud y el rendimiento de los animales.
Las estrategias de mitigación, como la selección de variedades de sorgo con menor contenido de estos compuestos, el uso de técnicas de procesado adecuadas y de aditivos, son esenciales para garantizar el uso seguro y eficaz del grano.
Liberando el potencial del sorgo en la alimentación de aves de corral y cerdos DESCARGAR EN PDF



Alba Cerisuelo
Investigadora Alimentación
Animal en el IVIA

Los “antiguos alimentos” (FF, del inglés
“Former foodstuffs” ) se definen en el Catálogo de materias primas para piensos (REGLAMENTO (UE) 2017/1017A) como los:
“productos alimenticios, distintos de los residuos de cocina, elaborados para el consumo humano cumpliendo plenamente la legislación alimentaria de la UE, que ya no estén destinados al consumo humano por motivos prácticos o de logística o bien por problemas de fabricación, defectos de envasado o deficiencias de otra índole y que no supongan ningún riesgo para la salud cuando se utilicen como piensos”.

Estos alimentos pueden ser reutilizados para alimentación humana y, cuando ya no es posible, pueden revalorizarse para alimentación animal. En el contexto actual de escasez de recursos y búsqueda de la sostenibilidad de los procesos, la lucha contra el desperdicio alimentario es ya una necesidad.


A nivel mundial, se desperdician o pierden alrededor de un tercio de los alimentos que se producen. Uno de los eslabones de la cadena alimentaria donde más desperdicio se ha detectado es en la industria agroalimentaria, como consecuencia del proceso de producción y la eliminación de productos que han perdido valor alimentario por no cumplir ciertos criterios de calidad comercial exigidos por el mercado como calibre, color, peso, defectos de forma,… o por estar fuera de temporada (excedentes de temporada de Navidad u otras celebraciones destacadas).
Estos productos pueden dar lugar a los llamados FF.
Es importante clarificar que los FF no son residuos (“waste” ) sino que son ingredientes que forman parte de la cadena alimentaria, tal y como se reconoce en la Directiva (EU) 2018/851. Por este motivo, los FF están cubiertos por la legislación actual sobre alimentación animal y son ingredientes que están en el mercado y que son seguros.
En la Tabla 1 se recogen algunos de los FF que aparecen en el Catálogo de materias primas (Reglamento UE 68/2013) y que, por lo tanto, están autorizados para alimentación animal. Número
8.7.1

Subproductos lácteos
9.14.1
13.1.1
13.1.2
13.1.3.
Productos de origen animal
Productos de panadería y de fabricación de pastas alimenticias
Productos de la industria de la pastelería
Productos de la elaboración de cereales para desayunos
13.1.11.
13.1.12.
Productos y subproductos de la elaboración de salsas
Productos y subproductos de la industria de los aperitivos salados
Obtenidos en la elaboración de productos lácteos (que incluyen antiguos productos lácteos, residuos de centrifugación o separación, agua blanca o minerales de leche, pero no se limitan a ellos).
Antiguos alimentos que contengan productos de origen animal y que pueden estar tratados o no, en estado fresco, congelado o seco.
Obtenidos durante y a partir de la producción de pan, galletas, obleas o pasta. Pueden ser secos.
Productos obtenidos durante y a partir de la producción de pasteles y tartas. Pueden ser secos.
Sustancias o productos destinados a ser consumidos por seres humanos o que, dentro de lo razonablemente previsible, pueden ser consumidos por seres humanos, en sus formas transformadas, parcialmente transformadas o sin transformar. Pueden ser secos.
Sustancias obtenidas de la producción de salsas, destinadas a ser consumidas por seres humanos o que, dentro de lo razonablemente previsible, pueden ser consumidas por seres humanos, en sus formas transformadas, parcialmente transformadas o sin transformar. Pueden ser secos.
Obtenidos durante y a partir de la elaboración de aperitivos salados: patatas fritas, aperitivos a base de patata y/o cereales (aperitivos directamente extruidos, a base de masa o granulados) y frutos de cáscara.
Humedad
Proteína bruta Grasa bruta Azúcares totales, expresados en sacarosa
Proteína bruta Grasa bruta
Contenido de humedad, cuando sea > 8 %.
Almidón
Azúcares totales, expresados en sacarosa
Grasa bruta, cuando sea > 5 %
Almidón
Azúcares totales, expresados en sacarosa
Grasa bruta, cuando sea > 5 %
Proteína bruta, cuando sea > 10 %
Fibra bruta
Aceites y grasas brutos, cuando sean > 10 % Almidón, cuando sea > 30 % Azúcares totales, expresados en sacarosa, cuando sean > 10 %
Grasa bruta
Grasa bruta
Tabla 1. Clasificación de algunos antiguos alimentos (FF, del inglés “former foodstuffs”) según el Catálogo de Materias Primas (Reglamento UE 68/2013).


materias primas para piensos del capítulo 9 (Productos de animales terrestres y sus productos derivados), éstos deberán cumplir los requisitos establecidos en los Reglamentos (CE) n.o 1069/2009 y (UE) n.o 142/2011, y podrán estar sujetas a restricciones de uso con arreglo al Reglamento (CE) n.o 999/2001.
Por lo tanto, en lo que se refiere a FF que contengan productos de origen animal, hoy en día, en Europa sólo están permitidos los que contienen o derivan de la leche, huevos, miel y gelatina de origen porcino.

Debido a su heterogeneidad, los nutrientes que son necesarios declarar de cada uno de ellos son diferentes, aunque la proteína, grasa y los azúcares son los más destacados en todos ellos. Al ser productos ya elaborados y preparados para su comercialización en la cadena alimentaria, el proceso de obtención es el mismo que se utiliza para producir estos productos para el consumo humano, y también lo son los requisitos de seguridad e inocuidad. Sin embargo, para algunos de ellos será necesaria una adaptación posterior a su obtención (deshidratación, desembalaje, molienda, tamizado,…) para poder ser incorporados en piensos y raciones para animales.
Como es de suponer, la composición química de estos ingredientes está muy ligada a su origen y no todos están descritos en las tablas de alimentos para animales. En este sentido, según Tretola (2018), estos alimentos pueden dividirse en diferentes categorías según origen:
Restos de la industria alimentaria, compuestos principalmente de productos de panadería (pan, pasta, etc.)
Productos de confitería (chocolates, galletas, etc.)
Otros productos secos (dulces, lácteos en polvo, etc.)
Productos húmedos (productos lácteos, bebidas, salsas, etc.)
En la Tabla 2 se muestra la composición media de algunos ingredientes considerados como FF, incluidos en las principales tablas de alimentos. En general, estos suelen ser alimentos ricos en almidón, grasas y/o azúcares, por lo que suelen representar una fuente de energía importante para los animales.
Sin embargo, estos pueden ser muy variables en composición, incluso dentro de una misma categoría de producto. En este sentido, algunos estudios sugieren que es necesario que estos productos sean procesados en una industria intermedia para asegurar una cierta homogeneidad y mayores estándares de calidad (Pinotti et al., 2021).


Tabla 2. Composición química (en materia seca) de algunos ingredientes considerados antiguos alimentos (FF, del inglés “former foodstuffs”)
FEDNA. VALORES EXPRESADOS EN MATERIA SECA
Por otro lado, algunos estudios sugieren que la mezcla de varios FF para formar un único ingrediente puede mostrar características nutricionales similares a los cereales, y definen estas mezclas como versiones fortificadas de los cereales comúnmente utilizados como fuente de energía en piensos (Giromini et al., 2017).
En la Tabla 3 se muestra una comparativa de la composición media de varias mezclas de FF y el grano de trigo donde se observa que el aporte de proteína y fibra es similar entre ellas, mientras que el aporte en grasa y energía digestible es más elevado en el caso de la mezcla de FF en comparación con el cereal.
INRAE-CIRAD-AFZ. VALORES EXPRESADOS EN MATERIA SECA
Materia seca, %
de FF
de 6 mezclas)
en
Adaptado de Giromini et al. (2017)
Tabla 3. Composición de una mezcla de antiguos alimentos (FF, del inglés “former foodstuffs”) y trigo.


El aporte de grasa a través de estos ingredientes es importante, ya que evita o reduce la cantidad de grasa libre a añadir en los piensos, mejorando así la calidad del gránulo.
La elaboración de mezclas es especialmente interesante para los FF que están disponibles en pequeñas cantidades o para los que, por su composición, el límite de inclusión se presupone bajo.
Es importante mencionar que, además de utilizarse como ingredientes propiamente dichos, algunos FF, especialmente aquellos ricos en azúcares (como por ejemplo, los caramelos o siropes) pueden utilizarse en sustitución de melazas, con el objetivo de dar mayor consistencia al pienso durante la peletización (Raamsdonk, et al., 2011).
A pesar de que por su composición, digestibilidad y palatabilidad, los FF son una valiosa fuente de nutrientes en alimentación animal, en la actualidad, la parte de estos ingredientes que es reprocesada para alimentación animal es aún muy baja, en comparación con la parte que se trata como residuo y se elimina (EFFPA, 2023).
Algunas de las razones por las que no se destinan más FF en alimentación animal son la variabilidad en su composición, la falta de información sobre los efectos sobre el rendimiento y salud de los animales, aspectos sobre seguridad en animales y consumidores, percepción de los consumidores y aspectos relacionados con la logística de algunos FF (falta de conexión entre la industria alimentaria y la fabricación de piensos).

En términos de especies destino, por sus características, estos ingredientes pueden funcionar muy bien en piensos de porcino y aves, aunque también en rumiantes pueden tener un papel importante.

En las dietas, estos productos reconocen como potenciales sustitutos de cereales en términos energéticos y también de minerales. Estudios realizados en vacas de leche sugieren que la inclusión de FF en las dietas (15 y 30%) puede aumentar el consumo de materia seca, la digestibilidad de la materia orgánica y producción de leche de los animales (Kaltenegger et al., 2020)
Sin embargo, a nivel fecal, la inclusión de FF puede dar lugar a una pérdida de diversidad en la microbiota fecal y, por lo tanto, un mayor riesgo de disbiosis
En el caso del porcino, la mayoría de estudios se concentran en la fase postdestete. En este sentido, la inclusión de un 30% de FF en dietas de lechones destetados no parece afectar al rendimiento productivo, o incluso puede mejorar la eficiencia de transformación y la digestibilidad de los nutrientes (Luciano et al., 2021; Tretola et al., 2019).
Los efectos de estos ingredientes en la microbiota intestinal y los parámetros sanguíneos de los animales son muy variables entre estudios, y no concluyentes hasta el momento.
estudios es todavía muy bajo y presentan resultados contradictorios en términos de digestibilidad de los nutrientes (Stefanello et al., 2016; Zhang and Adeola, 2017).
En lo referido a seguridad, los dos aspectos que más preocupan en estos ingredientes son la calidad microbiológica y la presencia de residuos del embalaje (plásticos, aluminio,…).
Varios estudios en este campo indican que, en las muestras analizadas, el riesgo microbiológico es bajo y que el riesgo de contener residuos del embalaje puede ser minimizado mediante diferentes técnicas desarrolladas recientemente para este fin (Luciano et al., 2022).


A pesar del esfuerzo realizado hasta el momento para dar a conocer estos ingredientes, según Srikanthithasan et al. (2024), la información disponible sobre las consecuencias del uso de FF en alimentación animal es todavía insuficiente a nivel de composición (alta variabilidad entre los diferentes FF), valor nutricional en las diferentes especies, impacto en los rendimientos de los animales y fisiología digestiva y salud.
Además, la información relativa a la calidad de estas materias primas es casi inexistente
Por lo tanto, en los próximos años será necesario estudiar estos aspectos para impulsar el uso de estos ingredientes en la alimentación animal.
Por su composición y características legales, los FF son ingredientes alternativos muy prometedores en alimentación animal.
En el contexto actual, su inclusión en piensos supone una vía para reducción del desperdicio alimentario y la competencia entre alimentación humana y animal, así como una oportunidad de convertir los recursos no aprovechables de la cadena alimentaria en recursos de alto valor nutricional y más económicos para alimentación animal, en línea con el concepto de economía circular que promulga la Unión Europea.

Antiguos alimentos (Former Foodstuffs)
DESCÁRGALO EN PDF
Sin embargo, para impulsar el uso de FF en fábricas de piensos es esencial aumentar el conocimiento con respecto a sus propiedades nutricionales y funcionales, así como garantizar su seguridad en términos de salud y calidad de los productos de origen animal.
Además, será importante en el futuro clasificar estos ingredientes según volumen, composición, necesidad de acondicionado y establecer posibles cadenas de suministro de cada uno de ellos.
Referencias bibliográficas disponibles en la versión web del artículo.


EFICACIA ESPECÍFICA SOBRE LA/S MICOTOXINA/S INFORMACIÓN ADICIONAL PAÍSES DE AMÉRICA LATINA DONDE EL PRODUCTO ESTÁ DISPONIBLE
DOSIS
Argentina, Brasil, Bolivia, Chile, Colombia, Ecuador, Guatemala, Honduras, México, Nicaragua, Panamá, Perú, Costa Rica, República Dominicana, Uruguay y El Salvador
Inactivadores de micotoxinas que protegen a los animales de los efectos nocivos de este contaminante con hasta cinco mecanismos de acción diferentes:
1) ADSORCIÓN: Secuestrando las micotoxinas para que sean excretadas sin ser adsorbidas.
Argentina y Brasil
2) BIOINACTIVACIÓN: Cambio de las estructuras químicas de las micotoxinas a metabolitos menos tóxicos y/o más fáciles de excretar.
3) REVITALIZACIÓN DEL SISTEMA INMUNE: Protegiendo la respuesta inmune normal que es suprimida por micotoxinas.
Eficacia sobre un amplio espectro de micotoxinas, polares y apolares, probados mediante pruebas in vitro e in vivo La bentonita (1m588) presente en estos productos está aprobada en la Unión Europea como ingrediente adsorbente de micotoxinas.
Bolivia, Chile, Colombia, Ecuador, México, Perú y Uruguay
4) DEFENSA ANTIOXIDANTE: Previene el daño celular mediante el manejo efectivo del estrés oxidativo causado por micotoxinas.
5) PROTECCIÓN DE ÓRGANOS: Prevención de daños y apoyo al funcionamiento normal de órganos sensibles a micotoxinas.
Argentina, Brasil, Chile, Colombia, Ecuador, Costa Rica, Panamá, México y Uruguay
0,5-2,5 kg/t
0,5-2,5 kg/t
0,5-2,5 kg/t
COMPOSICIÓN
Unike Plus® a Arcillas modificadas con alta capacidad de adsorción (bentonita 1m588 y sepiolita); a Levadura inactivada y extractos de levadura (Saccharomyces cerevisae) a Antioxidantes celulares; a Compuestos de hierbas.
Unike a Arcillas modificadas con alta capacidad de adsorción (bentonita 1m588 y sepiolita); a Levadura inactivada y extractos de levadura (Saccharomyces cerevisae) a Antioxidantes celulares; Compuestos de hierbas.
Toxy-Nil
Plus® a Arcillas modificadas con alta capacidad de adsorción (bentonita 1m588 y sepiolita); a Levadura inactivada y extractos de levadura (Saccharomyces cerevisae) a Antioxidantes celulares.
Toxy-Nil
1-3 kg/t
Toxy-Nil® a Arcillas modificadas con alta capacidad de adsorción (bentonita 1m588 y sepiolita); a Levadura inactivada y extractos de levadura (Saccharomyces cerevisae)
EFICACIA ESPECÍFICA SOBRE LA/S MICOTOXINA/S INFORMACIÓN ADICIONAL PAÍSES DE AMÉRICA LATINA DONDE EL PRODUCTO ESTÁ DISPONIBLE
DOSIS
Disponible en la mayoría de los países de América Latina.
Disponible en la mayoría de los países de América Latina. *Consulte las diferentes alternativas con su representante local.
Micotoxinas pertenecientes a los grupos: micotoxinas de Aspergillus micotoxinas de Penicillium zearalenonas, fumonisinas, ácido fusárico, tricotecenos tipo A y B, ocratoxinas, y micotoxinas de Ergot. Cuenta con más de 159 publicaciones científicas, 23 artículos revisados, 22 pruebas In Vitro, 109 pruebas In Vivo, 5 publicaciones en métodos de análisis y 43 maestrías y doctorados.
Micotoxinas pertenecientes a los grupos: micotoxinas de Aspergillus micotoxinas de Penicillium y micotoxinas de Fusarium. Para uso ante una contaminación con micotoxinas de menor riesgo y para animales monogástricos como cerdos en crecimiento-finalización y pollos de engorde.
Unidos,
COMPOSICIÓN
Mycosorb A+ a Glucanos extraídos de pared celular de especies seleccionadas de levaduras (Saccaromyces cerevisiae) y de algas (Chlorella vulgaris) por un proceso patentado por Alltech Inc 0,5 a 2 Kg/tm
MICO LR™ a Contiene componentes seleccionados de la pared celular de la levadura. 0,5 a 1kg/tm
Leche: Vacas lactantes: 28 g/hd/día
México, Guatemala, El Salvador, Honduras, Costa Rica, Panamá, República Dominicana, Nicaragua, Colombia, Ecuador, Venezuela, Perú, Chile, Argentina, Brasil, Uruguay, Paraguay, España, Corea del Sur, Japón, Filipinas, India, China, Malasia
Brasil y Centro América
Estados
Fórmula lista para ser usada por fábricas de piensos y Productores. Tenga en cuenta que, debido a los diferentes requisitos de registro, la descripción de los ingredientes es ligeramente diferente en los distintos países. Consulte con los representantes regionales para confirmar.
Eficacia de amplio espectro frente a múltiples micotoxinas: aflatoxina, fumonisina, ocratoxina, DON, T2 y zearalenona
Carne: Engorde en corrales y vacas: 10-15 g/hd/día Cerdos: Cerdas 2Kg/Tonelada Lechon: 2 kg/ton
BG-MAX™ Midds or BG-MAX™ Preparación de RFCs™ (Carbohidratos Funcionales Refinados™) biológicamente activos y Bentonita
Crecimiento y Finalizacion: 1 kg/ton
Aves: 1 kg/ton
Adsorbente de micotoxinas de amplio espectro de acción
B.I.O.Tox® a Bentonita a Productos de levadura a Carbón vegetal a Sepiolita

EFICACIA ESPECÍFICA SOBRE LA/S MICOTOXINA/S INFORMACIÓN ADICIONAL PAÍSES DE AMÉRICA LATINA DONDE EL PRODUCTO ESTÁ DISPONIBLE
DOSIS
Atrapante de micotoxinas altamente eficaz que adsorbe las micotoxinas más peligrosas. Funciona independientemente de los niveles de pH, y proporciona una acción rápida contra las micotoxinas después de la ingestión del pienso. Es un producto selectivo que no se interfiere con la absorción de nutrientes esenciales como vitaminas y aminoácidos, y está exento de compuestos tóxicos (ej. dioxinas y metales pesados).
De 0.5 a 3.0 kg/t de pienso, en función del nivel de contaminación por micotoxinas. a Aflatoxina B1 (AFB1) a Zearalenona (ZEA) a Toxina T-2 a Fumonisina B1 (FB1 ) a Ocratoxina A (OTA) a Toxinas alcaloides del ergot (AEs)
COMPOSICIÓN
BIŌNTE® QUIMITŌX® a Bentonitas (1m558; 1m558i) a Arcilla sepiolítica
África, Asia, Europa, LATAM y Oriente Medio.
Eficacia evaluada basada en estudios toxicocinéticos y biomarcadores de exposición a micotoxinas en diferentes especies de destino, según la normativa de la EFSA.
a Solución anti-micotoxina de triple acción: adsorción a Bioprotección a Efecto postbiótico a Efectivo contra: Aflatoxinas (AFB1, AFB2, AFG1 y AFG2), Fumonisinas (FB1, FB2 y FB3), Zearalenona (ZEA), Toxinas T-2 y HT-2, Ocratoxina A (OTA), Deoxinivalenol (DON; por desintoxicación), Toxinas alcaloides del ergot (AEs), Micotoxinas emergentes (Beauvericina: BEA; Enniatinas: ENN A, ENN A1, ENN B y ENN B1; Esterigmatocistina, ETC), Micotoxinas modificadas Zearalenona glucuronido (ZEA 14-G)
De 1.0 a 3.0 kg/t de pienso, en función del nivel de contaminación por micotoxinas.
BIŌNTE® QUIMITŌX® PLUS a Bentonitas (1m558; 1m558i) a Arcilla sepiolítica a Mezcla de extractos fitogénicos (extractos de cúrcuma y cardo mariano) a Pared celular de levadura y levadura hidrolizada
Complejo metabólico multiacción que mitiga los efectos colaterales de las micotoxinas como la alteración de la integridad intestinal, el estrés oxidativo y las alteraciones de los órganos diana: La administración de forma continuada, potencia los parámetros productivos y mejora la calidad de los productos animales (carne, huevo, leche).
De 1.0 a 2.0 mL/L de agua de bebida. a Una solución sistémica que aumenta la viabilidad celular, muestra actividad antimicrobiana contra Salmonella entérica , Shigella dysenteriae , Staphylococcus aureus y Yersinia enterocolitica ; mejora la calidad del agua y reduce la biodisponibilidad de las micotoxinas emergentes en el hígado (ácido tenzuanoico)
a Solución líquida a base de una mezcla de extractos fitogénicos (extractos de uva y oliva) a Minerales esenciales a Emulsionantes a Preservativos

Atrapante de micotoxinas para especies acuáticas que ofrece una solución completa para afrontar el reto de las micotoxicosis en acuicultura.
De 1.0 a 3.0 kg/t de pienso, en función del nivel de contaminación por micotoxinas. a Aflatoxina B1 (AFB1) a Ocratoxina A (OTA) a Zearalenona (ZEA) a Toxina T-2 a Fumonisina B1 (FB1)
BIŌNTE® QUIMITŌX® AQUA a Bentonita seleccionada (1m558i) a Arcilla sepiolítica a Aditivo fitogénico para piensos (Harina de corteza de naranja)
Solución anti-micotoxinas para especies acuáticas altamente sensibles a las micotoxinas y ficotoxinas con un triple modo de acción: adsorción, bioprotección y efecto postbiótico.
De 1.0 a 3.0 kg/t de pienso, en función del nivel de contaminación por micotoxinas. a Aflatoxinas a Fumonisinas a Toxinas T-2 y HT-2 a Deoxinivalenol (DON) a Micotoxinas emergentes (Beauvericina, Enniatinas, Esterigmatocistina) a Micotoxinas modificadas
BIŌNTE® QUIMITŌX® AQUA PLUS a Bentonita seleccionada (1m558i) a Arcilla sepiolítica a Mezcla de extractos fitogénicos (extractos de cúrcuma y cardo mariano) y emulsionante a Pared celular de levadura y levadura hidrolizada
EFICACIA ESPECÍFICA SOBRE LA/S MICOTOXINA/S INFORMACIÓN ADICIONAL PAÍSES DE AMÉRICA LATINA DONDE EL PRODUCTO ESTÁ DISPONIBLE
DOSIS
México Panamá República Dominicana Ecuador Perú Chile Venezuela
COMPOSICIÓN
Antimicotoxicósico de triple acción: a Mecanismo de atrape físico. a Mecanismo de atracción polar. a Inhibición y destrucción.
De1 a 3 Kg./Tm de alimento, dependiendo del nivel de contaminación de micotoxinas a Amplio espectro de adsorción de micotoxinas: Aflatoxinas, Ochratoxina, T-2, Vomitoxina DON, Zearalenona. a Eficacia contrastada en experiencias “ in vivo ” e “ in vitro ”.
toxidex® a Mezcla de aluminosilicatos activados con tensoactivos y agentes destructores de micotoxinas
Myco-Marker® y la tecnología
La combinación del servicio
Escent® conforman la plataforma RISE®. El servicio Myco-Marker® permite por primera vez medir el impacto real de las micotoxinas en la salud y la productividad y optimizar la estrategia de mitigación con el detoxificador (Escent®). Escent® tiene múltiples modos de acción, todos los cuales han demostrado in vivo que ayudan a los animales a combatir el estrés:
Excelente eficacia demostrada in vivo contra las principales micotoxinas: a Deoxinivalenol a Aflatoxinas a Fumonisinas a Zearalenona a T-2 a Ocratoxina A a Cornezuelo a Micotoxinas emergentes
Escent® a Mezcla de arcillas a Levadura a Antioxidantes a Protectores hepáticos y renales» Aves de corral y cerdo 0,53 kg/T Rumiantes: 20-40 g/animal/día.
* Apoya el hígado y los riñones
* Prevenir el estrés oxidativo
* Aumentar la respuesta inmunitaria * Aumentar la desintoxicación * Adsorber (mico)toxinas.-
Determinación de 36 biomarcadores de micotoxinas clave para conocer el impacto real de las micotoxinas en los animales.
Análisis de piensos y sangre a partir de una sola gota (mediante una tarjeta FTA) sin limitaciones de transporte.
Aditivo Anti-micotoxinas con efecto detoxificante y mejorador de resultados zootécnicos. En Argentina, FINTOX MOLD PLUS es conocido como LIPTOMIC PLUS. Para más información contactar con: liptosa@liptosa.com Tel: +34 91 725 08 00
Adsorbente y detoxificante de amplio espectro eficaz frente a micotoxinas y otras endotoxinas con efecto depurativo. Puede actuar como agente hepatoprotector. En Argentina, FINTOX PRO ADVANCE es conocido como LIPTOMIC PRO ADVANCE.
AFB1, AFB2, AFG1, AFG2, AFM1 ZEA T-2 OTA FB1 DON Citrinina Fumitoxina
Adsorbente y detoxificante de amplio espectro, libre de componentes minerales.
Myco-Marker®
Fintox Mold Plus a Arcillas seleccionadas a Ácidos orgánicos a Levaduras y sus partes 1-2 Kg/t de alimento en función del grado de contaminación.
Fintox Pro Advance a Arcillas seleccionadas a Levaduras y sus partes a Fructooligosacáridos a Extractos botanicos a Betaína a Antioxidante natural 1-2 Kg/t de alimento en función del grado de contaminación.
Fintox Pro Nature a Levaduras y sus partes a Algas marinas a Fructooligosacáridos a Extractos botanicos a Betaína a Antioxidantes naturales 1-2 Kg/t de alimento en función del grado de contaminación.
EFICACIA ESPECÍFICA SOBRE LA/S MICOTOXINA/S INFORMACIÓN ADICIONAL PAÍSES DE AMÉRICA LATINA DONDE EL PRODUCTO ESTÁ DISPONIBLE
DOSIS
Monogástrica: 0,5-3 kg por tonelada de pienso final Rumiantes: 30-120 g / cabeza/ día a Aflatoxina a Zearalenona a Alcaloides del ergot a Ocratoxina A a Endotoxinas bacterianas a Inactivación de toxina = adsorción (AFL, OCT, ZEN, Ergots) + capacidad máxima de aglutinación de endotoxinas
COMPOSICIÓN
MiaBond a Bentonita (1m558 )
Monogástrica: 0,5-3 kg por tonelada de pienso final Rumiantes: 30-120 g / cabeza/ día a Aflatoxinas a Zearalenona a Ergotamina a Endotoxinas a Inactivación de toxina = adsorción (AFL, OCT, ZEN, Ergots) + capacidad máxima de aglutinación de endotoxinas a Protección celular avanzada = mezcla de compuestos polifenólicos
M iaBond BP a Bentonita (1m558) a Mezcla de compuestos polifenólicos
Para más información, contactar con: toxininactivation@miavit.de
Monogástrica: 1-3 kg por tonelada de pienso final Rumiantes: 30-120 g / cabeza/ día a Aflatoxina a Zearalenona a Alcaloides del ergot a Ocratoxina A a Fumonisina B1 y B2 a Todos los tricotecenos (DON, DAS, etc.) a Endotoxinas bacterianas a Inactivación de toxinas = adsorción (AFL, OCT, ZEN, ERGOT) + biotransformación (DON) + biodegradación (FUM) a Protección celular = mezcla de compuestos aromatizantes a Equilibrio GI = combinación de inactivación de toxinas e ingredientes naturales
M iaBond 360 a Bentonita (1m558) a Bacterias anaeróbicas para biotransformar tricotecenos (p. ej., DON) a Enzima esterasa para biodegradar las FUM a Mezcla de compuestos aromatizantes
Cerdos y aves de corral: 100-200 g/ 1000 l de agua de bebida a Fumonisina B1 a Fumonisina B2 a Inactivación de toxinas = biodegradación (FUM) a Potenciador del GI = efectos sinbióticos de probióticos y prebióticos + inactivación de toxinas a Inmunomodulador = mezcla de ingredientes naturales
M iaBond Drink a Enzima esterasa (1m03i) para biodegradar FUM a Mezcla de ingredientes naturales a Mezcla de probióticos y prebiótico a Fuentes de energía
360 A qua a Bentonita y clinoptilolita a Mezcla de compuestos aromatizantes a Elemento traza orgánico a Compuesto prebiótico Peces y gambas: 0,5-3 kg por tonelada de pienso final a Aflatoxina a Zearalenona a Alcaloides del ergot a Ocratoxina A a Endotoxinas bacterianas a Adhesión de toxinas = bentonita y clinoptilolita a Apoyo a la disminución del amoníaco = clinoptilolita a Inmunomodulador y protección celular = elemento traza orgánico, mezcla de compuestos aromatizantes y compuestos prebióticos
M iaBond
EFICACIA ESPECÍFICA SOBRE LA/S MICOTOXINA/S INFORMACIÓN ADICIONAL PAÍSES DE AMÉRICA LATINA DONDE EL PRODUCTO ESTÁ DISPONIBLE
DOSIS
COMPOSICIÓN
Chile, Uruguay, Colombia, Ecuador, Bolivia, El Salvador, Honduras, Guatemala, México, Panamá, Perú y República Dominicana
Principales ventajas distintivas de Free-Tox® XP: a Eficaz en baja dosis a Alta capacidad de adsorción de una amplia gama de micotoxinas, tanto a niveles de contaminación bajos y altos a No adsorbe vitaminas o minerales y a La adsorpción permanece estable a través del tracto digestivo a Resistente a altas temperaturas a Mejora la inmunidad y favorece el rendimiento de la producción a Ayuda a inhibir el crecimiento de hongos a Estimula la salud del hígado
Free-Tox® XP es un adsorbente de micotoxinas de amplio espectro, que es muy eficaz en baja dosis. a Tiene una excelente capacidad de adsorción de una amplia gama de micotoxinas, tanto a niveles de contaminación bajos y altos a La adsorción permanece estable a través del tracto digestivo con sus diferentes niveles de pH a Mejora la inmunidad y favorece el rendimiento de la producción a Ayuda a inhibir el crecimiento de hongos a Estimula la salud del hígado
Se utiliza de forma preventiva como adsorbente de micotoxinas en caso de contaminación confirmada o sospechada de las materias primas o alimentos balanceados. Se puede utilizar en todas las especies y edades, y puede añadirse directamente en el alimento o a través de la premezcla. Dosificación 0,52 kg/tonelada de alimento completo
Free-Tox® XP contiene una mezcla de adsorbentes cuidadosamente seleccionados, incluidos varios tipos de silicatos procesados y combinados para garantizar una capacidad de adsorción de amplio espectro, adicionado con componentes purificados de la pared celular de levadura (Saccharomyces cerevisiae) que contribuyen a la modulación del sistema inmunitario animal, e inhibidor de crecimiento de hongos.
Free-Tox® XP
Chile, Brasil, Colombia, Uruguay, República Dominicana, Ecuador, Bolivia, El Salvador, Honduras, Guatemala, México, Panamá, Perú
Principales ventajas distintivas de Endoban®: a Eficaz en baja dosis a Mejora el aprovechamiento de los nutrientes y la energía a Protege de los efectos negativos de las endotoxinas a Aditivo alimentario único e innovador a Aumenta la ganancia de peso y la producción
Desde un principio, EndoBan® se desarrolló específicamente como una herramienta de prevención contra las endotoxinas y el estrés inflamatorio inducido por estas, y no como un derivado de un atrapante de micotoxinas existente. De este modo, es único en cuanto a la magnitud y eficacia de su enfoque para reducir la pérdida de rendimiento productivo relacionada con las endotoxinas. EndoBan® tiene una gran capacidad para eliminar los altos niveles de endotoxinas que se encuentran en el tracto intestinal de monogástricos, rumiantes y especies acuáticas, aumentando así su rendimiento productivo y su ganancia.
EndoBan® contiene una mezcla de ingredientes ampliamente investigados, seleccionados y procesados específicamente para conseguir una alta capacidad de eliminación de endotoxinas, entre los que se incluyen diversos silicatos y extractos de plantas que refuerzan adicionalmente el sistema de defensa del animal frente a las endotoxinas. Las endotoxinas están siempre presentes en los animales, en particular en su tracto digestivo, incluso sin contaminación del alimento o del agua. Las endotoxinas desafían continuamente al sistema inmunitario, reduciendo así el crecimiento y la capacidad de producir carne, huevos o leche a bajocosto. Por ello, se aconseja el uso continuo de EndoBan® de forma preventiva para reducir el estrés inflamatorio inducido por las endotoxinas y favorecer el crecimiento y la eficacia de la producción. EndoBan® es seguro en todas las especies y edades, y eficaz a dosis bajas. Dosis recomendada: 0,5-2 kg/tonelada.
Principales beneficios distintivos de Endoban® FT: a Eficaz a dosis bajas a Mejora el rendimiento y la eficiencia alimentaria estimulando un tracto gastrointestinal sano y reduciendo el estrés inflamatorio a Alta capacidad de eliminación de micotoxinas y endotoxinas a No adsorbe vitaminas o minerales a La adsorción permanece estable a través del tracto digestivo a Resistente a altas temperaturas a Estimula la salud del hígado a Ayuda a inhibir el crecimiento de hongos
Endoban® FT combina lo mejor de ambos mundos: suprime los riesgos de micotoxinas y endotoxinas eliminándolas del tracto gastrointestinal antes de que puedan ejercer sus efectos tóxicos y favoreciendo así el crecimiento y el rendimiento productivo.
EndoBan® FT se utiliza como herramienta de defensa preventiva contra el impacto negativo de las micotoxinas y endotoxinas que tienen efectos negativos sinérgicos sobre el crecimiento animal y el rendimiento productivo. EndoBan FT es seguro de usar en todas las especies y edades, y eficaz a dosis bajas. Dosificación 1,53 kg/MT
EndoBan® FT es una mezcla optimizada de EndoBan® y Free-Tox® XP, que contiene la combinación óptima de silicatos cuidadosamente seleccionados y procesados para garantizar una eliminación óptima de micotoxinas y endotoxinas, adicionada con componentes purificados de la pared celular de levadura (Saccharomyces cerevisiae) y extractos de plantas para apoyar el sistema inmunitario del animal y su mecanismo de defensa contra las endotoxinas, así como un inhibidor del crecimiento de hongos.
EFICACIA ESPECÍFICA SOBRE LA/S MICOTOXINA/S INFORMACIÓN ADICIONAL PAÍSES DE AMÉRICA LATINA DONDE EL PRODUCTO ESTÁ DISPONIBLE
DOSIS
En la mayoria de los paises de America Latina
a FIX HP: La silimarina de estos productos actúa como un potente hepatoprotector y el selenio orgánico actúa como un antioxidante natural. a FIX FUSION: La silimarina de estos productos actúa como un potente hepatoprotector.
a FIX S: La silimarina de estos productos actúa como un potente hepatoprotector y el selenio orgánico actúa como un antioxidante natural.
Mezclar homogéneamente en la ración total, de 0,5 a 2,5 Kg/t de pienso, dependiendo de la contaminación. Aplicación en fábrica de piensos. a Adsorbe micotoxinas complejas, como DON, FB1 y ZEA, así como micotoxinas más sencillas como AFB1 y OTA.
COMPOSICIÓN
a AFLA +++ a ZEA +++ a OTA ++ a FUM +
Aves 0,5 -2,0kg/ton; Cerdos (crecimento y terminación) 1,0kg/ton; Cerdos (preiniciador, iniciador, reproducción y lactancia) 2,0kg/ton; Equinos y mulas 1,0-2,0kg/ton; Perros y gatos 1,0-3,0kg/ ton; Peces y camarones 1,0-2,0kg/ton; Ovejas y cabras 1,0-2,0kg/ton; Bovinos 1,0-2,0kg/ton. a AFLA +++ a ZEA +++ a OTA ++ a DON + a FUM +
a AFLA +++ a ZEA + a OTA +
Bentonita
Mananooligosacáridos Betaglucanos Silimarina
MT.X+
Mananooligosacáridos
Bentonita Carbón vegetal
Betaglucanos Selenio Silimarina
FIX HP
Mananooligosacáridos
Bentonita Carbón vegetal
Betaglucanos
FIX FUSION
Selenio Silimarina
Betaglucanos, mananoligosacaridos, carbón vegetal, silimarina, bentonita y selenio.
FIX S
EFICACIA ESPECÍFICA SOBRE LA/S MICOTOXINA/S INFORMACIÓN ADICIONAL PAÍSES DE AMÉRICA LATINA DONDE EL PRODUCTO ESTÁ DISPONIBLE
DOSIS
COMPOSICIÓN
México
Zeotek® a Aluminosilicato de calcio y sodio activado químicamente con un compuesto orgánico (Organoaluminosilicato) a Preventiva: 0.751.0 kg/ton a Casos clínicos: 1.5 kg/ton a Aflatoxinas a Fumonisina B1 a Ocratoxina A a Toxina T2 a Zearalenona a Planta productora de adsorbentes trabaja bajo el sistema de seguridad alimentaria HACCP, cuenta con acreditación ISO 22000 y certificación FAMI QS, ademas de contar con laboratorios con la capacidad instalada para realizar pruebas in vivo e in vitro, acreditados ante la Norma Oficial Mexicana 17025 para laboratorios de ensayos y calibración, cuenta con métodos acreditados ante la EMA y Certificados de Buenas Prácticas de Manufactura (GMP’s) expedido por SADER. a Todos los productos son evaluados por el laboratorio de referencia Trilogy Analytical Labs, con resultados satisfactorios. Los productos son libres de dioxinas (Eurofins Analytics France [Nantes]), metales pesados y otros contaminantes microbiológicos, siendo esto último evaluado a través del método de cuenta de bacterias aerobias en placa, conforme a lo establecido en la NOM-092-SSA1-1994.
D uotek® a Aluminosilicato de calcio y sodio activado parcialmente con un compuesto orgánico (Organoaluminosilicato) a Preventiva: 1.02.0 kg/ton a Casos clínicos: 3.0 kg/ton a Aflatoxinas a Fumonisina B1 a Ocratoxina A a Toxina T2 a Zearalenona

Bolivia, Chile, Colombia, Ecuador, El Salvador, Guatemala, Honduras, Nicaragua, Panamá, Perú. Para más información consulte a su asesor más cercano www.trouwnutritionlatam.com/contacto
TOXO®-XL ayuda a mitigar el deterioro del desempeño animal cuando hay riesgo de contaminación por multi-micotoxinas. Las esmectitas de TOXO®-XL son altamente eficaces en la reducción de la biodisponibilidad de las micotoxinas. La fórmula de TOXO®-XL contiene biopolímeros de la glucosa específicamente seleccionados y B-glucanos purificados para reforzar la función de la barrera intestinal y el sistema inmune, que son afectados principalmente por las micotoxinas de Fusarium, tales como los Tricoticenos y Fumonisinas. TOXO®-XL no liga nutrientes haciéndole apropiado y seguro para su uso en el alimento balanceado y en las premezclas.
Bolivia, Colombia, Costa Rica, República Dominicana, Ecuador, EL Salvador, Guatemala, Honduras, Nicaragua, Panamá, Perú. Para más información consulte a su asesor más cercano www.trouwnutritionlatam.com/contacto
TOXO®-MX es un agente secuestrante de micotoxinas en base a esmectitas puras y activadas. TOXO®-MX ayuda a los animales de producción a mantener un estatus saludable sin comprometer los parámetros productivos en caso de exposición a aflatoxinas. Secuestra aflatoxinas de manera efectiva en el tracto gastrointestinal, promoviendo por tanto su excreción antes de que sean absorbidas y pasen a la sangre. TOXO®-MX no liga nutrientes haciéndole apropiado y seguro para su uso en el alimento balanceado y en las premezclas.
Zeolex® Extra a Aluminosilicato de calcio y sodio a Preventiva: 2.5 kg/ton a Casos clínicos: 5.0 kg/ton a Aflatoxinas a Fumonisina B1
TOXO-XL a Contiene bentonita a base de esmectita cuidadosamente seleccionada y altamente purificada, con biopolímeros de glucosa que refuerzan las uniones estrechas de los enterocitos para una buena integridad intestinal, y β-glucanos rigorosamente purificados para promover la modulación inmunológica del animal. 0,5-2 kg por tonelada de alimento balanceado a Aflatoxinas a Deoxynivalenol (DON) a Toxina T-2 a Fumonisina a Ocratoxina a Zearalenona

TOXO-MX a Contiene bentonita a base de esmectita cuidadosamente seleccionada y altamente purificadas. 1,0 –3,0 kg por tonelada de alimento balanceado a Aflatoxinas

Ing. Químico Bessone Patricio - Departamento técnico comercial Avícola – CLADAN SA Nutrición y Salud Animal

Es conocido a nivel mundial que la prevalencia de micotoxinas tanto en materias primas como en los alimentos ha ido incrementándose en los últimos años y esto ha producido un aumento, no sólo en la investigación acerca del impacto a nivel del rendimiento productivo en las aves, también ha crecido el interés por los productores en poder analizar y controlar este tipo de toxinas que hace un tiempo relativamente corto se han convertido en nuevos desafíos.
En la siguiente gráfica, podemos observar en el tiempo el aumento de determinaciones de micotoxinas realizadas por nuestro laboratorio.


Gráfica 1. Cantidad de micotoxinas analizadas mensualmente por año
Las micotoxinas son metabolitos secundarios de algunas especies de hongos filamentosos y existen más de 200 especies que las producen.
Dentro de las principales causantes de daños en el metabolismo y en consecuencia pérdidas económicas en la producción de proteína animal, se encuentran
Aflatoxina B1, Zearalenona, Ocratoxina, Fumonisina, Tricotecenos como el Deoxinivalenol y T2 dentro del grupo que afectan en el caso de los animales monogástricos como pollos y cerdos.
Está comprobado científicamente que la presencia de micotoxinas, ya sea por partidas con altos niveles o por ingesta acumulativa de las mismas, provoca efectos negativos en las aves afectándolas no sólo de forma subclínica.
Se pueden llegar a presentar también hematomas y hemorragias, afecciones en ciertos órganos como el hígado y el riñón, inmunosupresión, lesiones orales, alteraciones en la digestión, absorción o alteraciones en el metabolismo de los nutrientes y un aumento notable en la morbilidad y la mortalidad.
Claro está que todas estas consecuencias provocarán pérdidas de resultados técnicos y, en consecuencia, económicas.
Desde nuestro lugar, siendo meros observadores de la realidad, al analizar los datos de los distintos productores vemos que, en muchas ocasiones, la teoría puede no coincidir con los resultados obtenidos. Existen casos en dónde los altos niveles de toxinas afectan a unos más que a otros o simplemente algunos no evidencian síntomas que provoquen bajas en los resultados.
Por éstas razones nos pueden surgir preguntas tales como:
¿Estamos midiendo correctamente?
¿La cantidad y el tipo de análisis que realiza una empresa, están acordes con el desafío del momento? ¿La producción de cereales en distintas zonas del país presenta niveles parecidos en un mismo período?
¿Cuáles son mis límites máximos de tolerancia o riesgo de micotoxinas ante distintos desafíos?
Por ejemplo, podemos observar como la producción de cereales en distintas zonas del país (Argentina) puede llegar a presentar niveles de micotoxinas más variados y con una frecuencia mayor dependiendo la ubicación de las mismas.
A
Gráfica 2. Comparativa de niveles de micotoxinas en dos zonas productivas diferentes
Zona productiva B
La idea de poder observar, analizar y contar éste caso nace debido a que los resultados productivos de una integración avícola argentina en ésta época del año, en donde la variable climática baja su incidencia en los mismos, han sufrido una baja considerable y atípica.
Si bien el desafío de micotoxinas ha sido más elevado para éstos meses en relación a las mismas fechas del año pasado, se ha observado que en otros momentos del año el desafío ha sido similar pero no ha causado un impacto tan severo en el desempeño de los animales.
Esto nos conduce a tratar de entender cuáles fueron (o son) las diferencias en ambos casos.
Para realizar el análisis, graficaremos los niveles de micotoxinas totales encontradas, expresadas como suma de éstas para poder visualizar mejor el impacto y a su vez se mostrarán variaciones en los índices de conversión tanto de la integración como una de las granjas modelo para poder descartar variables que puedan distorsionar los resultados.
Gráfica 3. Niveles de micotoxinas y relación con el índice de conversión





Granja Ejemplo IC Integración Avícola Suma total Micotoxnas (ppm)
Al comparar ABR23 con ABR24, podemos observar un empeoramiento en el índice de conversión de 2,1% para la integración y de un 7,7% para la granja modelo.
Para la línea que representa el nivel de micotoxinas (Gráfica 3), en el mes de Abril 2024 contamos con el pico más elevado en la gráfica. Es decir, la cantidad de micotoxinas halladas en ése mes es el mayor para todo el período evaluado. Además, si miramos a partir de Enero 2024 podemos notar que los niveles son ascendentes a medida que transcurren los meses a diferencia de lo que ocurre en el 2023.
Para poder analizar con mayor precisión lo ocurrido con el índice de conversión, deberemos revisar la mortandad para descartar que éste parámetro no sea el principal causante de la variación en el IC.
Gráfica 4. Niveles de micotoxinas y relación con el índice de conversión

En ambos casos, tanto para la Integración como la granja modelo, la mortandad se ha reducido un 15,4% y un 15% respectivamente.
Esto nos muestra que, si bien puede llegar a existir mortandad consecuencia de altos niveles de micotoxinas, el alto nivel de las mismas no se corresponde con un aumento de mortandad de forma lineal para éste caso y en consecuencia no logra justificar un incremento en los índices de conversión.
Gráfica 5. Niveles de micotoxinas y relación con la mortalidad

Ahora bien, volvamos a la Gráfica 3 y evaluemos los resultados en los meses de Julio y Agosto del 2023. En estos meses, la suma de micotoxinas no son despreciables, de hecho representan 2 de los 4 picos más elevados en la gráfica.
Si analizamos la variación en los índices de conversión para éstos meses observaremos que ésta es positiva e indica mejores índices que otros momentos del período como es el caso de Abril 2024, pero además en ésta ocasión el factor climático juega negativamente debido a que estamos en pleno invierno con temperaturas muy frías.
Por lo tanto, ¿a qué se debe que los índices de conversión y sus respectivos pesos sean mejores en éstos meses a pesar de tener niveles de micotoxinas elevados tal como lo fue en Abril 2024?
Una de las hipótesis de esto podría estar relacionada con el consumo.
A menudo en granjas avícolas, se han observado lesiones a nivel de cavidad oral, las cuales afectan el consumo de las aves y a los parámetros productivos por la disminución de este consumo de alimento. Las apariencias de estas lesiones, que consisten en la presencia de erosiones y úlceras, generalmente son atribuibles a micotoxinas del género Fusarium como los tricotecenos.
En un análisis realizado recientemente con un N de 4.575 datos, se muestra la alta correlación entre el consumo medio diario y la ganancia media diaria. n=4575
R2=0,6209
Gráfica 6. Correlación entre el consumo medio diario y la ganancia media diaria


Por lo tanto, procederemos a evaluar cómo estuvo el consumo durante los distintos períodos en nuestro caso…

Consumo diario Integracón Avícola Consumo diario Granja ejemplo Suma total Micotoxnas (ppm)
Gráfica 7. Niveles de micotoxinas y relación con el consumo medio diario
Se destacan las diferencias de consumos entre los períodos Jul/Ago 2023 y Abril 2024, pero también se hace mención específica a la disminución del mismo entre Abril 2023 y Abril 2024.
Esto induce a preguntarnos: ¿Se podría suponer que ante un mismo nivel elevado de desafío de micotoxinas el mayor consumo redujo la pérdida de performance?, o ¿el blend de micotoxinas prevalente encontrando fue distinto al período Abr24 y no ocasionó pérdidas de consumo?

Luego de haber analizado y contado lo sucedido, consideramos conveniente que cada empresa reevalúe sus controles de calidad, su frecuencia de análisis, la estrategia de uso de aditivos y cada uno de los miembros de un equipo interdisciplinario trabaje en conjunto cuestionándose y analizando todo aquello que genere incertidumbre para luego poder definir la estrategia de límites máximos de micotoxinas convenientes para cada empresa dependiendo del momento que se esté transitando. No cabe duda que los altos niveles de micotoxinas provocan pérdidas en los rendimientos productivos generando así pérdidas económicas.

Las preguntas para realizar un buen análisis de datos pueden ser:
¿Qué hay de diferencia entre las distintas zonas productivas? ¿Se siembra distinto? ¿Los suelos son distintos? ¿Los tiempos de siembra y de cosecha son distintos?
¿Los altos niveles de micotoxinas afectarán más si existe una enfermedad primaria o secundaria? ¿Debo modificar mis límites de aceptación?
¿El mayor consumo, puede mitigar el desafío? ¿Los nutrientes de las materias primas, tales como la energía, se verán afectados?
¿Habrá que compensar la formulación con más nutrientes ante un alto desafío de éste tipo?
Observando a las micotoxinas: cómo pueden impactar y bajo qué condiciones (Caso práctico) DESCÁRGALO EN PDF


Cinta Sol, Phd
Felipe Horta, MSc
OBJETIVO
MATERIAL Y MÉTODOS
TRATAMIENTOS
El objetivo de este estudio fue investigar la eficacia de PeptaSan™ sobre la viabilidad de esporozoítos de E. tenella y E. maxima in vitro.
La prueba de viabilidad de los esporozoítos se realizó en Poulpharm (Bélgica), siguiendo el procedimiento interno estandarizado donde esporozoítos recién excitados de E. tenella y E. maxima fueron expuestos a PeptaSan™ y otros productos como Salinomicina en una dosis efectiva a nivel de luz intestinal correspondiente a 60ppm en el alimento. Los esporozoítos viables fueron contados a las 0h, 24h, 48h y 72h.
1. Control negativo (PBS)
2. Control de solventes (PBS con 1% de DMSO)
3. Salinomicina (12g/ton diluida en DMSO)
4. PeptaSanTM (500g/ton diluido en DMSO)
DISEÑO EXPERIMENTAL
RESULTADOS
Los recuentos se realizaron a las 0h, 24h, 48h y 72h post-incubación y la reducción de la viabilidad (expresada como porcentaje de reducción) se determinó con base en la concentración inicial.
Porcentaje de reducción de la viabilidad de esporozoítos de E. tenella en presencia de diferentes productos
% de reducción de la viabilidad
Horas de incubación
*indican diferencia estadística entre los grupos en cada tiempo (p<0,05)
PBS
DMSO
Salinomicina
PeptaSanTM
% de reducción de la viabilidad
Porcentaje de reducción de la viabilidad de esporozoítos de E. maxima en presencia de diferentes productos
Horas de incubación
PBS
DMSO
Salinomicina
PeptaSanTM
*indican diferencia estadística entre los grupos en cada tiempo (p<0,05)
Para E. tenella se observó una reducción similar de esporozoítos viables con PeptaSan™ y Salinomicina. Para E. maxima, PeptaSanTM superó a la salinomicina con una reducción completa de esporozoítos a las 24h, que se mantuvo a lo largo del tiempo. PeptaSan™ mostró un patrón de reducción similar para ambas especies de Eimeria.
Con base en este ensayo in vitro, PeptaSanTM mostró una fuerte reducción de esporozoítos de E. tenella y E. maxima con eficacia similar o mejor que la Salinomicina. Este estudio demuestra objetivamente que PeptaSan™ tiene un efecto directo sobre las coccidias, reduciendo el número de esporozoítos viables para la invasión del epitelio intestinal. En conjunto con estudios anteriores, donde se probaron sus efectos sobre la mucosa intestinal de las aves, el presente estudio demuestra que PeptaSan™ tiene efectos tanto sobre la causa como sobre la consecuencia de la coccidiosis, mostrando ser una herramienta interesante para su control.

Eficacia in vitro de PEPTASAN™ sobre la viabilidad de esporozoítos de Eimeria spp.
Descargar PDF


La nutrición es uno de los eslabones más importantes y esenciales en la producción animal, es por eso que la calidad del alimento debe ser conservada a lo largo de toda la cadena de producción. Comenzando por la siembra de los cereales en el campo, el momento de cosecha y almacenamiento, control de calidad de materias primas y elaboración del alimento terminado.
Más importante aún, es proporcionar un ambiente donde ese alimento sea digerido y aprovechado eficientemente, esto se logra brindando una protección de la salud del sistema digestivo y de su ecología microbiana, para obtener los resultados de crecimiento, rendimiento y productividad esperados.
Una de las mayores amenazas que desde hace tiempo afectan la calidad y aprovechamiento del alimento por parte de los animales, es el crecimiento de ciertos hongos indeseables en los cereales, especialmente en el maíz, ingrediente principal en la ración de aves y cerdos en producción.
Estos hongos, ante momentos de estrés (ambiental, nutricional), generan metabolitos tóxicos, conocidos como micotoxinas, que, al ser ingeridos por los animales, alteran su salud y por lo tanto la capacidad de producción.


En base a los relevamientos que hemos realizado durante los últimos 8 años, las Fumonisinas son las micotoxinas más prevalentes. Esto se debe a que provienen de un género de hongo particular, los Fusarium (principalmente F. verticilloides y F. proliferatum), que se encuentran ampliamente distribuidos ya que son capaces de crecer en condiciones ambientales muy variables.
Además, afectan las raíces de las plantas, por lo que permanecen en el campo, infectando las siembras sucesivas. Otro gran problema de estos hongos es que no solo producen Fumonisina, sino también Tricotecenos y Zearalenona.
Debido a esto, las Fumonisinas se encuentran en prevalencias promedio de entre el 60 y el 80% y con concentraciones medias de 2000 ppb. Sin embargo, los métodos analíticos suelen detectar principalmente FB1, por lo que otras formas como FB2 y FB3 pueden estar presentes, pero no ser detectadas.
El principal modo de acción de la Fumonisina
B1, la más común, es la inhibición de una enzima que participa en la síntesis de esfingolípidos, los cuales integran más del 40% de los lípidos de la membrana plasmática.
El incremento y el desbalance de estos lípidos bioactivos explican muchos de los efectos en las células animales.
Mallmann, C.A. & Dilkin, P (2013), mencionan que las intoxicaciones crónicas son más frecuentes que los brotes agudos, las cuales se producen al ingerir cantidades moderadas de Fumonisinas a largo plazo. Las aves presentan alteraciones de la salud intestinal e inmunosupresión y signos subclínicos como disminución del rendimiento productivo, del consumo de alimento, la ganancia de peso y alteraciones de la conversión alimenticia, entre otros.
Si bien las Fumonisinas son polares y son capaces de ser adsorbidas por los secuestrantes, su gran tamaño y elevado peso molecular hace que sea necesarias grandes concentraciones de estos para poder eliminar la totalidad del desafío.
Es por esto por lo que los inactivadores enzimáticos son una gran opción para el control y la prevención del daño que ocasionan las Fumonisinas.
Detoxa FUMO® / Detoxa Goal Poultry® (DF y DGP) es un inactivador enzimático producido por Pichia Pastoris y formulado con pared de levadura de Saccharomyces Cerevisiae. Posee la enzima esterasa, específica para Fumonisina. A su vez, también contiene secuestrantes que tienen espectro de acción para Aflatoxina.
Para poder demostrar la actividad de las enzimas del producto, se llevaron a cabo ensayos in vitro e in vivo. Los ensayos in vivo se realizaron en la Universidad del Estado de Santa Catarina, Brasil.

Debido a que las enzimas de DF/DPG actúan a pH ácido, el ensayo se realizó imitando las condiciones del tracto digestivo superior de las aves. Se simuló el contenido gástrico (pH, temperatura, tiempo de exposición, enzimas, presencia de alimento) y se realizó un desafío de 5000 ppb de Fumonisina.

grupos experimentales, con 7 repeticiones de 15 aves cada una para un total de 105 aves por tratamiento.
Los animales fueron alojados en boxes a piso durante 42 días. Las aves pertenecientes al grupo desafiado recibieron en la dieta, de forma constante, un desafío de 30.000 ppb de Fumonisina B1.
Los grupos experimentales fueron los siguientes:
CN: No desafiado y sin DF/DGP
CP: Desafiado y sin DF/DGP
T1: Desafiado y con DF/DGP a 500 gr/t
T2: Desafiado y con DF/DGP a 1000 gr/t
se evaluó la digestibilidad, parámetros histológicos y bioquímica sanguínea.
Se utilizaron 140 aves, divididas en 4 grupos experimentales, con 7 repeticiones cada uno de 5 aves para un total de 35 aves por tratamiento. Las aves ingresaron con 25 semanas de vida y se mantuvieron hasta las 41 semanas.
Aquellas pertenecientes al grupo desafiado recibieron en la dieta, de forma constante, un desafío de 30.000 ppb de Fumonisina B1.


Los grupos experimentales fueron los siguientes:
CN: No desafiado y sin DF/DGP
CP: Desafiado y sin DF/DGP
T1: Desafiado y con DF/DGP a 500 gr/t
T2: Desafiado y con DF/DGP a 1000 gr/t
Además de los resultados productivos, se evaluó la digestibilidad, parámetros histológicos, bioquímica sanguínea y calidad de huevos.
Para todos los resultados, letras diferentes en la misma columna de la tabla, indican diferencias significativas según test de Tukey (P<0,05).
Para todos los resultados, letras diferentes en la misma columna de la tabla, indican diferencias significativas según test de Tukey (P<0,05).
Valores medios obtenidos para consumo de ración (CR, g), ganancia de peso (GP, g), conversión alimenticia (CA, g/g) y viabilidad (VL, %)

Medias obtenidas para digestibilidad (%) de materia seca (MS), proteína bruta (PB), extracto etéreo (EE) y materia mineral (MM)
valor <0,0001 <0,0001 <0,0001 <0,0001
Medias obtenidas para el largo de la vellosidad, profundidad de Cripta y relación vilo/cripta (V/C)
Medias obtenidas para Aspartato Aminotransferasa (AST, U/L), Especies Reactivas del Oxígeno (ROS), Superóxido Dismutasa (SOD, U/μL), Glutatión Peroxidasa (GPx, nmol/mL.min-1)

Como se puede observar, el desafío fue lo suficientemente fuerte como para alterar algunos de los parámetros evaluados.
Con respecto a los resultados zootécnicos, solo se vio perjudicada la conversión alimenticia, esto seguramente esté relacionado con la disminución de la digestibilidad de nutrientes observada, lo que se explica por la disminución del desarrollo del intestino.
Este cuadro de mal desarrollo intestinal y síndrome de mala absorción es característico de las exposiciones crónicas a Fumonisina.
Los grupos con DF/DGP fueron capaces de compensar, de forma parcial o total, estos problemas en cada uno de los parámetros, disminuyendo el impacto productivo que tiene la exposición de esta micotoxina en la producción.
Valores médios obtidos para producción de huevos (PP, %), consumo de ración (CR, g), peso de huevo (PO, g), masa de huevos (MO, g/ave/día) y conversión alimenticia (CA).

Medias obtenidas para digestibilidad (%) de materia seca (MS), proteína bruta (PB), extracto etéreo (EE) y materia mineral (MM)
73,01 B 59,71 B 81,59 B 47,43
75,60 AB 73,86 A 83,88 AB 54,09
74,05 AB 72,94 A 85,38 AB 48,30
valor 0,035 0,016 0,0018 0,511
Medias obtenidas para el largo de la vellosidad, profundidad de Cripta y relación vilo/cripta (V/C)
En el caso de aves de larga vida, el desafío no tuvo el mismo impacto que en las aves de corta vida. Esto probablemente se deba a que la exposición a las toxinas se realizó con aves ya adultas, las cuales tienen una susceptibilidad menor. No se vieron diferencias significativas en la calidad de huevos y en la bioquímica sanguínea.
Sí se pudo observar una disminución marcada en la producción de huevo, de igual forma que en aves de corta vida, debido a la disminución de la absorción de nutrientes, lo que se debe al menor desarrollo del intestino. Ensayos de eficacia de Detoxa Fumo / Detoxa Goal Poultry DESCÁRGALO EN PDF
De igual forma, Detoxa Fumo / Detoxa Goal Poultry fue capaz de compensar, parcial o totalmente, estas disminuciones, protegiendo a las aves del desafío tóxico de la Fumonisina.


Juan Gabriel Espino Nutrólogo independiente
El agua es el nutrientes más importante en producción porcina, aunque pareciera que se analiza poco y no se le da el lugar que le corresponde dentro de un perfil nutricional.
Representa el 80% de peso vivo de un animal joven y el 60% de un animal adulto.



Se localiza en 3 diferentes compartimientos a nivel fisiológico:
Espacio extracelular
Espacio intracelular (fracción más abundante)
Espacio sanguíneo
El agua cumple las siguientes funciones en el organismo de un cerdo
Durante la ingesta de comida, el agua ayuda en la deglución de los alimentos. En un animal que no consume agua, la deglución se vuelve un proceso difícil de realizar y el alimento se acumula en el esófago.
El agua ayuda a hidratar el bolo alimenticio a nivel estomacal; el alimento ingerido por los animales puede llegar a contener hasta un 85% de materia seca.
El agua puede representar entre el 60% al 90% del volumen celular. Por eso constituye un componente primordial en la estructura de cualquier célula del organismo.

Aparato de Golgi

Esa materia seca, debe de hidratarse ya que las paredes del estómago no tienen la capacidad de hidratar el alimento que recibe del esófago.

Membrana plasmática mitocondria
Retículo endoplasmático
lisosoma vesícula
membrana nuclear peroxisoma
citosol
Figura 1. En la figura de arriba se observan los organelos de una célula. En la figura de abajo, lo resaltado en celeste es el citoplasma, constituido por un alto porcentaje de agua.

El agua tiene una alta capacidad calorífica, lo que significa que puede absorber y liberar grandes cantidades de calor sin experimentar cambios drásticos en su temperatura. Esta característica ayuda a mantener la homeostasis térmica.


Figura 2.
La temperatura ambiental puede llegar a fluctuar durante el día. Si se incrementa, como la imagen del lado derecho, el cerdo debe de termoregularse para mantener la temperatura corporal. La evaporación resulta ser el mecanismo más eficiente para disipar ese incremento de calor corporal.
El agua también desempeña un papel central en la homeostasis ácido-base. El pH del agua es 7, muy cercano al pH fisiológico ideal de la mayoría de los tejidos.
Por lo tanto, incentivar la ingesta de agua en época de calor es la estrategia más importante a implementar.
Además, el agua es una parte integral del sistema tampón de bicarbonato, por el cual el CO₂ y el H₂O están en equilibrio con el H+ y el HCO−3:
De esta manera, el agua participa en el mecanismo responsable de excretar la mayor cantidad de ácido producido por el metabolismo normal en el cuerpo, es decir, a través del CO₂.
El sistema del bicarbonato, en asociación con la hemoglobina en la sangre, apoya la eliminación de una molécula que de otro modo sería tóxica, el CO₂, con poco daño a los tejidos y pocos cambios en el pH venoso.

anteriormente y el de soluto que
Como disolvente, el agua es el principal medio de transporte para el intercambio de nutrientes, energía química, metabolitos y productos de desecho entre células y entre órganos.

También favorece el movimiento de las hormonas desde su lugar de producción o liberación hasta las células u órganos diana o ambos.
Su éxito como disolvente radica en su estructura química única, es decir, el carácter dipolar de la molécula.
Por ejemplo, la sal simple se disuelve fácilmente en agua, pero es casi insoluble en otros líquidos como el benceno o el cloroformo (Lehninger, 1982).

El agua también la encontramos en líquidos extracelulares cumpliendo diferentes funciones.
El líquido sinovial, el cual lo encontramos en las articulaciones, funciona como lubricante.
El líquido cefalorraquídeo se localiza en el sistema nervioso central, funciona como un medio para amortiguar los movimientos del sistema nervioso con las paredes del cráneo.
El agua es la base de las reacciones químicas del organismo, como la oxidación y la hidrólisis. La oxidación interviene en la degradación de los aminoácidos dietéticos que no se utilizan en los procesos sintéticos, y de los carbohidratos y lípidos dietéticos que no se depositan directamente en el organismo.
Dado que aproximadamente dos tercios de las proteínas dietéticas no se retienen en el organismo y la mayor parte de los carbohidratos dietéticos se oxidan, esto representa una fuente sustancial de agua metabólica, la cual se estima en un alrededor del 12% del balance hídrico diario total en el cerdo en crecimiento.
El agua es un recurso muy importante dentro de la producción porcina. Puede ser el medio por el cual lleguen bacterias indeseables o minerales que pueden producir efectos negativos en la producción. Es por eso que la calidad de agua se divide en tres categorías:
Las características físicas son el aspecto macro como se observa el agua a simple vista. Esta inspección se divide en:
La turbidez es más un atributo estético que de calidad. Una turbidez alta puede representar simplemente material coloidal suspendido, como limo o arcilla. En niveles bajos, esto significa muy poco para la producción.
Sin embargo, también puede representar microorganismos suspendidos, que pueden ser de gran importancia. Por lo tanto, la turbidez es una medida que puede considerarse más cualitativa que cuantitativa.

Si tiene una turbidez de menos de 5 unidades de turbidez nefelométricas (NTU), entonces probablemente sea aceptable para los cerdos. Si la turbidez es superior a 5 NTU, entonces se deben realizar mediciones adicionales del contenido químico y microbiológico del agua para determinar su causa.

El color, medido en unidades de color verdadero (TCU), no es una preocupación para el agua potable suministrada al cerdo, a menos que se deba a un contaminante indeseable.
Otros análisis serán de mucho mayor valor para el cerdo que el color, y estos incluyen sólidos disueltos totales, sulfato, dureza y microbiología.
El olor, se mide en número umbral de olor (TON). El agua dulce debe estar casi libre de olores.
Si están presentes, la causa de los olores desagradables puede ser de importancia, por lo que se justifica un análisis más profundo. La causa más probable es la contaminación microbiológica
Este análisis hace referencia a los componentes del agua y los niveles aceptables de estas variables para evitar alguna alteración en la producción.
Los SDT son utilizados como medio para determinar la idoneidad del agua potable para los cerdos. Los sólidos disueltos totales se deben principalmente a la presencia de bicarbonato, cloruro y sales de sulfato de sodio, calcio y magnesio.
En general, si los SDT son bajos (es decir, inferiores a 1000 mg/L), la contaminación mineral no puede ser un problema y no se requieren más pruebas.
Si los TDS están entre 1000 y 3000 mg/L, pueden causar diarrea transitoria, en particular en cerdos jóvenes.
Esto sería particularmente cierto

La dureza es una medida de los cationes multivalentes presentes en el agua, principalmente calcio y magnesio en forma de carbonatos, bicarbonatos, sulfatos y cloruros.
El sulfato es una sal que se encuentra de forma natural en la mayoría de las fuentes de agua subterránea, pero que suele estar en una concentración lo suficientemente baja como para no causar problemas.
La dureza no tiene ningún impacto conocido en la salud de los animales, pero sí perjudica el lavado debido a una mayor necesidad de jabón o detergentes.
Aunque el tracto intestinal del cerdo está bien provisto de transportadores que pueden absorber sulfatos, a menudo estos se vuelven a secretar en el intestino grueso, lo que provoca diarrea osmótica. También puede provocar la acumulación de sarro en los equipos de suministro, tratamiento y calentamiento del agua.
Por lo tanto, la dureza del agua puede provocar problemas con los calentadores de agua, bebederos de tetina y filtros.
No se conocen problemas de salud directos asociados con niveles elevados de hierro y manganeso en el agua potable, pero pueden causar problemas de manipulación. Sin embargo, en algunos casos, los sulfatos pueden superar los 1000 mg/L, que generalmente se considera el umbral aceptable para el agua potable de los cerdos.
Ambos minerales tienden a existir en las aguas subterráneas en su forma reducida y, por lo tanto, son solubles. Sin embargo, a medida que se extrae agua del pozo y se expone al oxígeno, se oxidan y se vuelven insolubles.


El hierro oxidado tiene un tono marrón rojizo típico, mientras que el manganeso tiende a ser más oscuro, casi negro.
Si están presentes en el agua, se pueden ver en la decoloración persistente de inodoros y lavabos, pero lo que es más crítico, recubren los elementos de los calentadores de agua, bebederos, cloradores y otros.
El hierro en el agua no debe superar los 0,3 mg/L, aunque pueden producirse manchas en niveles tan bajos como 0,1 mg/L (Chinn, 2009). El nivel de manganeso no debe superar los 0,05 mg/L (Chinn, 2009)

Sorensen et al. (1994) alimentaron a cerdos con niveles aún más altos de nitratos, hasta 2000 ppm, desde el destete hasta el mercado y no observaron efectos adversos en ningún criterio de rendimiento de crecimiento ni en los niveles de hemoglobina o metahemoglobina en la sangre.
El hierro también puede contribuir al crecimiento de bacterias.
Los nitratos y nitritos son una preocupación particular en el agua potable para humanos porque los bebés son particularmente susceptibles al síndrome del “bebé azul”, llamado así porque los nitratos y nitritos se unen a la hemoglobina, reduciendo su capacidad de transportar oxígeno y formando metahemoglobina.
El ganado vacuno es mucho más susceptible a los nitratos que los cerdos porque las bacterias del rumen convierten los nitratos en nitritos, mucho más peligrosos. Garrison et al. (1966) informaron que 200 mg de nitratos/L perjudicaban la tasa de crecimiento y el metabolismo de la vitamina A.
El sodio no es un problema en el agua por sí solo. Sin embargo, los cationes como el sodio están asociados con un anión en el agua.
Si este anión es sulfato, provocará diarrea ya que el sulfato de sodio es un potente laxante.
Si el catión es cloruro, no hay motivo de preocupación y si el catión es carbonato o bicarbonato, el agua puede tener un pH más alto.
Es importante tener en cuenta que los ablandadores de agua simples de intercambio iónico reemplazan el calcio y el magnesio con sodio y, por lo tanto, elevan los niveles de sodio en el agua.
Por sí solo no representa un problema en el agua. Como se mencionó anteriormente, contribuye a la dureza del agua.
Además, está asociado con un anión que lo contrarresta; si el anión es sulfato, tiene un potente efecto laxante en el cerdo.
La calidad microbiológica suele considerarse el tema principal en las discusiones sobre la calidad del agua. La presencia de organismos patógenos en el agua puede provocar brotes de enfermedades en el rebaño y hacer que sea casi imposible lograr el máximo nivel de rendimiento.
Normalmente, el cloruro no se encuentra elevado en las aguas subterráneas ni en las superficiales. Si es elevado (> 400 mg/L), le dará un sabor metálico al agua, que hasta ahora no parece afectar negativamente al cerdo.

Las aguas superficiales corren el mayor riesgo debido a la mayor probabilidad de contaminación.
Por ejemplo, el agua puede contener bacterias como salmonella, shigella y campylobacter; virus como enterovirus; y protozoos como cryptosporidium y giardia. Además, ciertas algas en el agua pueden provocar gastroenteritis.

El agua es el nutriente más importante de la dieta, con un marcado efecto en la nutrición y composición de tejidos. Es por eso que es imprescindible el conocimiento de su calidad, para así poder tomar las medidas correctivas en caso de ser necesarias, y volverla apta para la
ANTECEDENTES
S. Jalukar1, C. Rippe, y S. Fribourg2
1 Arm & Hammer Animal Nutrition, Princeton, NJ
2 Adisens, Peru
OBJETIVOS
MÉTODOS DE ENSAYO
RECOPILACIÓN DE DATOS ANÁLISIS DE DATOS
Los beneficios de la suplementación con CELMANAX en las dietas de cerdas y lechones en crianza sobre el rendimiento de estos animales ya se habían observado anteriormente1,2. Sin embargo, se han supuesto beneficios a largo plazo en los cerdos en etapa de finalización en función de pesos más elevados en crianza, pero no se habían documentado previamente.
El primer objetivo era evaluar el beneficio para el rendimiento de las cerdas, de la suplementación con CELMANAX un mes antes del parto y durante la lactancia. El segundo objetivo era medir el beneficio de la suplementación continua con CELMANAX en crianza sobre el rendimiento de los cerdos en etapa de finalización..
El estudio se llevó a cabo en un establo de investigación comercial en Perú. Las cerdas (PIC) (18-27 por corral) alojadas en 6 corrales se asignaron a dos tratamientos, tres corrales (réplicas) por tratamiento. Una semana antes de la fecha prevista del parto, las cerdas fueron trasladadas a jaulas de parto individuales. T Las cerdas fueron alimentadas con dietas de gestación y lactancia sin CELMANAX (control) o con CELMANAX SCP 200 g/TM un mes antes de su fecha de parto y en lactancia.
A los lechones se les proporcionó alimento complementario y fueron destetados a los 21 días de edad. Los cerdos destetados fueron transferidos a múltiples corrales de crianza, 35 cerdos en cada corral. Los cerdos destetados de cerdas alimentadas con control recibieron una dieta de control en la crianza y los de cerdas alimentadas con CELMANAX recibieron CELMANAX SCP, 200 g/TM durante la crianza.
Se administraron dietas convencionales de crianza a base de maíz y harina de soya, con sustituto de leche y plasma (5% Fase 1, 4% Fase 2 y 2,5% Fase 3) conteniendo niveles farmacológicos de Óxido de Zinc y antibióticos. Fases 1 y 2 - Doxiciclina (1,2 Kg/TM) aproximadamente 10 – 20 mg/kg de peso corporal (PC) y en Fases 3 y 4 - Florfenicol (1,5 Kg/TM) aproximadamente 2,5 – 10 mg/kg de PC. No se usó el suplemento CELMANAX durante la fase de crecimiento y finalización.
En el caso de las cerdas, se midió el intervalo destete-celo (IEC) y el porcentaje de preñez. Se midió el peso corporal de los lechones al nacer, al destete y al final de la crianza, y el porcentaje de supervivencia antes del destete. Se midió el peso en canal y la eficiencia alimentaria (EF) cuando los cerdos fueron comercializados.
No se realizó ningún análisis estadístico.
La suplementación con CELMANAX redujo el tiempo de destete hasta el estro de las cerdas (Figura 1). Los datos de rendimiento de las cerdas, los lechones de destete y los lechones en etapa de crecimientoengorde se presentan en la Tabla 1. Los lechones de las cerdas suplementadas con CELMANAX fueron más pesados al nacer y al destete. La suplementación con CELMANAX en las dietas de destete mejoró la ganancia de peso en la etapa de destete y redujo la relación alimentación/ganancia (Tabla 1). Como resultado, los cerdos del grupo CELMANAX fueron 2,4 kg más pesados en comparación con los cerdos de control al final de la etapa de destete. Aunque CELMANAX no se suplementó en la etapa de crecimiento-engorde, los cerdos que recibieron CELMANAX durante la etapa de destete tuvieron un peso en canal 5,4 kg mas y una relación alimentación/ganancia reducida al final del período de crecimiento-engorde en comparación con los cerdos de control (Tabla 1).
Figura 1. Intervalo desde destete al estro (en días) para las cerdas estudiadas.
DESCRIPCIÓN
Ingesta de alimento (30 d gestación + lactancia), kg/cerda
Cerda alimentada con Celmanax,
sobrevida pre-destete
Peso corporal del lechón al nacer, kg
Peso corporal del lechón al destete, kg
CRIANZA
Peso Corporal al final de criadero, 70 días de edad, kg
Aumento de peso corporal en el criadero
Ingesta de alimentos acumulado en criadero
FINALIZACION
Peso en canal a la terminación, kg
Eficiencia de Alimento, Alimento/Ganancia en crecimiento a terminación
Ingesta de alimentos (30 d gestión + lactancia), kg
Cerda alimentada con Celmanax, kg
Costo de alimento de cerda (incl. Celmanax), Soles/kg
de alimento para Cerda/lechón
a Estro, días
de recría, Soles/cerda
neto para cerdas (alimento + cría)
CRIANZA
Ingesta de alimento acumulativo en criadero
Costo de alimento en criadero (incl. Celmanax) /cerdo
ENGORDE-TERMINACIÓN Peso en canal al terminar, kg
ganados por cerdo
de alimento en soles/cerdo
Utilidad NETA por cerdo a la venta [precio de venta-costo de alimento (cerda + Criadero+ Ganancia por alimento)], soles
Utilidad adicional por cerdo con uso de CELMANAX, Soles
Costos fijos usados en el cálculo
Precio de carne de cerdo en el mercado, 5.8 Soles/kg,
Costo por día para impregnar a una cerda, 10.95 Soles
Costo acumulativo de alimento de engorde a terminación por cerdo, 219.00 Soles
INTRODUCCIÓN
CONCLUSIONES
REFERENCIAS
Una correlación directa entre peso corporal al destete y fase de terminación de crianza sobre índice de crecimiento en cerdos de engorde a terminación se a reportado con anterioridad3. Este estudio muestra que la suplementación con CELMANAX en dietas de cerdas y lechones condujo a utilidades adicionales de 28.33 Soles por cerdo al sacrificio (Tabla 2).
La suplementación con CELMANAX en la dieta de cerdos y lechones puede mejorar el rendimiento y utilidad para el productor porcino.
1. Benefits of mannan oligosaccharide (MOS) for sows and weanling pigs. Hung, and Lindemann (2009) Presented at the Midwest swine nutrition conference, Indianapolis., IN
2. Peng Ma, Guozhu C, Jalukar S. Evaluation of CELMANAX SCP supplementation in sow diets on piglet performance at weaning. J Anim Sci 2013; Vol. 91, E-Suppl. 2.
3. Post-weaning and whole-of-life performance of pigs is determined by live weight at weaning and the complexity of the diet fed after weaning* (2017) Collins et. al. Animal Nutrition 3 (2017)

La suplementación con CELMANAX en dietas de cerdas y lechones en el criadero mejoró el rendimiento de las cerdas y los cerdos de engorde en un ensayo de investigación comercial DESCARGAR EN PDF
Chantal Farmer
Agriculture and Agri-Food Canada, Sherbrooke Research and Development Centre, Sherbrooke, Québec, Canada
El sector porcino se enfrenta al problema de que las cerdas actuales no producen suficiente leche para mantener un crecimiento óptimo de sus camadas. Esto es especialmente difícil hoy en día, teniendo en cuenta los avances que se han hecho en la selección genética para producir camadas de mayor tamaño.
Aunque la producción de leche de las cerdas ha aumentado a lo largo de los años, esta se ha visto contrarrestada con creces por el aumento del número de lechones vivos al nacimiento, siendo imperativo desarrollar estrategias para aumentar la cantidad de leche disponible para los lechones lactantes.
El desarrollo mamario es un factor clave para la producción de leche y, sin embargo, no se han establecido los requisitos nutricionales para optimizarlo durante los periodos cruciales.
En este sentido, un nutriente de interés es la lisina, ya que es el principal aminoácido limitante en la mayoría de las dietas porcinas.
La lisina es más importante al final de la gestación, cuando se produce la mayor parte del crecimiento fetal y mamario.



Incremento de la cantidad de tejido sintetizador de leche para mejorar el rendimiento lácteo
En el Centro de Investigación y Desarrollo de Sherbrooke (Agriculture and Agri-Food Canada’s Sherbrooke Research and Development Centre) se llevaron a cabo dos proyectos para determinar el impacto de un aumento del 40% de la ingesta de lisina entre los días 90 y 110 de gestación sobre el desarrollo mamario de cerdas primerizas y multíparas. 1 2 3
El número de células mamarias presentes al inicio de la lactación es un factor clave que determina el potencial de producción de leche de la cerda (Figura 1) Por ello, todas aquellas medidas destinadas a intentar aumentar el número de células epiteliales mamarias tendrán efectos beneficiosos sobre el rendimiento durante la lactación.
Sin embargo, solamente se puede estimular el rápido desarrollo mamario mediante estrategias nutricionales o de otro tipo durante los periodos en los que ya se está produciendo.

Estos periodos de rápido desarrollo mamario ocurren en tres momentos distintos en la vida de una cerda:
Entre los 90 días de edad hasta la pubertad.
Desde los 90 días de gestación hasta el parto.
A lo largo de la lactación.
La nutrición al final de la gestación es muy prometedora para aumentar el número de células sintetizadoras de leche antes de que comience la lactación.




Lactación
90 días de edad - Pubertad 1 2 3 90 días de gestación - Parto

Figura 1. Incremento de la producción lechera de la cerda a través de un mayor desarrollo mamario (Creado con BioRender.com).
Aumentar el aporte de lisina al final de la gestación podría significar
Para evaluar el impacto de una alimentación con un 40% más de lisina al final de la gestación se alimentó a cerdas primerizas con 2,65 kg de una dieta convencional de maíz y harina de soja que proporcionaba:
A18,6 g de lisina digestible ileal estandarizada (SID)/día (según las necesidades estimadas).

B
26 g de lisina SID/día (↑40%) (la lisina adicional se obtuvo añadiendo más harina de soja a la dieta).
Ambas dietas tenían la misma cantidad de energía y se administraron entre los 90 y los 110 días de gestación, momento en el que las cerdas jóvenes fueron sacrificadas para
Si bien es cierto que la composición del parénquima mamario no se vio afectada por el tratamiento dietético, las cantidades totales de cada

Estos resultados indican que aumentar en un 40% la ingesta de lisina en cerdas primerizas al final de la gestación mejora el desarrollo de su tejido sintetizador de leche.
No obstante, es importante señalar que los efectos beneficiosos de la adición de harina de soja podrían deberse a un mayor contenido proteico o a mayores concentraciones de aminoácidos distintos de la lisina.
Por tanto, se puede concluir que el aumento de la cantidad de harina de soja para proporcionar un 40% más de lisina a las cerdas jóvenes durante el último tercio de la gestación podría ser beneficioso para la producción de leche en la siguiente lactación.
Más lisina al final de la gestación no se traduce en más leche en cerdas multíparas
Cuando se realizó un ensayo similar con cerdas multíparas (paridades 2 y 3), los resultados fueron diferentes.
Entre los días 90 y 110 de gestación, se alimentó a las cerdas multíparas con 2,6 kg de una dieta convencional de maíz y harina de soja que aportaba:
B
14,8 g de lisina SID/día (según las necesidades estimadas).
20,8 g de lisina SID/día (↑40%) (la lisina adicional se obtuvo añadiendo más harina de soja a la dieta).
A diferencia del ensayo con las cerdas primerizas, al analizar el tejido mamario el día 110 de gestación, no se observaron diferencias en la cantidad o composición del tejido sintetizador de leche.
Esto indica que la paridad afecta a la respuesta a la lisina suplementaria, observándose efectos beneficiosos para el desarrollo mamario en las cerdas primerizas, pero no en las multíparas.
Valdría la pena utilizar una estrategia de alimentación en dos fases al final de la gestación en cerdas primerizas, pero no en cerdas multíparas.
Las recomendaciones actuales no son suficientes para las cerdas primerizas
Los resultados de estos estudios ponen de manifiesto que las recomendaciones actuales de incluir lisina al final de la gestación en las dietas de las cerdas jóvenes están infravaloradas, pero son adecuadas para las dietas de las cerdas multíparas.
Aportando un 40% más de lisina en la dieta, con adición de harina de soja, los productores pueden estimular eficazmente el desarrollo del tejido sintetizador de leche durante la primera gestación, lo que conduce a una mejor producción de leche.

Suplementación de lisina al final de la gestación para estimular el desarrollo mamario de cerdas primerizas
DESCÁRGALO EN PDF
Seas nutricionista, agricultor o proveedor, enfrentas desafíos reales todos los días en la producción animal. Tu tarea es encontrar una solución a problemas complejos como enfermedades, presiones ambientales y más.
Ahora, puedes confiar en la experiencia confiable de los representantes de producción animal y alimentaria de Arm & Hammer en América Latina para proteger de manera proactiva a tus animales contra estas amenazas.

Guilherme Minozzo, Gerente de Desarrollo de Negocios LATAM y Jesús Mejia, Gerente de Negocios LATAM de Arm & Hammer Animal Nutrition, comparten sus experiencias trabajando para Arm & Hammer y cómo pueden ayudar a resolver los desafíos actuales en las operaciones lecheras, avícolas y porcinas de América Latina.
¿Qué es Arm & Hammer y qué hacen?
Arm & Hammer Animal Nutrition es una empresa global propiedad de Church & Dwight Co., Inc., fundada en 1846.
Church & Dwight posee muchas marcas de consumo populares, desde desodorantes y limpiadores hasta productos de cuidado personal y de mascotas, productos que probablemente tengas en tu hogar hoy.
En el ámbito de la producción animal, somos reconocidos como expertos en la cadena alimentaria. Ofrecemos soluciones innovadoras de nutrición animal enfocadas en generar un suministro de alimentos más seguro.
Estas soluciones también tienen un impacto positivo en la productividad animal y están diseñadas para reducir la necesidad de intervenciones costosas, mejorar el rendimiento animal y aumentar la rentabilidad.
A medida que nuevas presiones y factores del mercado influyen en la capacidad de producir alimentos seguros y asequibles, aumenta la necesidad de alternativas eficaces a los enfoques tradicionales.
¿Por qué se está enfocando Arm & Hammer sobre América Latina?
México producirá 50 millones de toneladas de alimento para animales para el 2030. Brasil producirá el doble. La producción animal tiende a crecer junto con la producción de granos, por lo que tiene sentido estar presente en América del Sur y otros países con una gran producción de granos.
Al mismo tiempo, el consumo de huevo, aves, carne de cerdo y leche también está aumentando. La disponibilidad de tierras sigue siendo la misma, por lo que debemos ayudar a los productores de leche, aves de corral y cerdos a ser lo más productivos posible.
Arm & Hammer está abordando desafíos globales, desde granjas hasta suministro de alimentos, y desarrollo de soluciones que funcionen a escala global en el futuro.
¿Cuál es la percepción de Arm & Hammer a nivel mundial?
Guilherme: Arm & Hammer es muy bien conocida en Norteamérica y esto empieza a nivel de consumidor.
Por ejemplo, un granjero estadounidense o canadiense pudiera despertar, cepillarse los dientes con pasta de dientes Arm & Hammer y luego recibir la visita de un representante de producción animal y alimentaria de Arm & Hammer.

Antes de que el representante diga nada, el granjero ya sabe que Arm & Hammer es sinónimo de calidad porque utiliza productos Arm & Hammer en su vida personal.
Actualmente, nuestros esfuerzos se centran en lograr que Arm & Hammer tenga un mayor reconocimiento internacional, extendiendo la misma percepción positiva de la empresa a otros países y presentando nuevos productos y tecnologías que ayuden a los productores de leche, aves y cerdos de América Latina.
Cuando un productor de México o Brasil vea el logotipo de Arm & Hammer, queremos que piense en calidad.
Arm & Hammer ya es conocida en México.
Cuéntanos sobre la percepción de la empresa allí.
Jesús: Hemos estado presentes en México desde 1988, es decir, desde hace más de 30 años. Arm & Hammer es conocida como una empresa con excelentes productos, alta integridad, calidad y consistencia, y somos constantemente reconocidos en México como una empresa honesta.

Somos vistos como pioneros en soporte técnico, tanto con productos como explorando ideas que mejoran la producción animal.
¿Por qué Arm & Hammer tiene una reputación tan honesta?
Arm & Hammer es una empresa que cotiza en la bolsa y, como empresa que cotiza en la bolsa, nos regimos por normas elevadas.
No probamos los productos en el campo con la esperanza de que funcionen. Antes de lanzar un producto, sabemos que funcionará porque hemos realizado la investigación correspondiente.
Aplicamos los mismos estándares a nuestros productos animales que a nuestros productos humanos porque hay mucho traslape de productos.
Nos aseguramos de que nuestros productos animales funcionen bien antes de lanzarlos al mercado porque necesitamos que productos comparables en el lado humano funcionen bien. Y si colocamos un producto en el estante de un supermercado, debe funcionar.

¿Cuál es el papel de Arm & Hammer en la nutrición animal?
Guilherme: El papel de Arm & Hammer es crear una nueva era en materia de salud animal, ofreciendo soluciones que favorezcan el medioambiente y el rendimiento animal.

Ahora mismo, los principales retos en América Latina son Clostridium perfringens, E. coli y salmonella. Es una región extensa, por lo que incluso entre dos lugares, las cepas de estos patógenos pueden ser diferentes. La salmonella en una región puede ser diferente a la salmonella en otra región.
Somos pioneros en la lucha por controlar los desafíos medioambientales de forma natural, como a través de la dieta de los animales.
Nos centramos en utilizar la dieta de los animales más allá de aportar valor nutricional, sino también en influir en otras áreas de la producción animal.
¿Qué desafíos singulares enfrentan los agricultores en América Latina?
Guilherme: Siempre estamos buscando los desafíos que enfrentan nuestros agricultores y la mejor opción para controlarlos. No se trata de un producto.
Nos esforzamos por descubrir lo que está sucediendo en la granja y luego encontramos la herramienta adecuada para corregir o solucionar el problema. La solución puede ser prevención o mitigación, o alguna otra cosa.
Para combatir estos patógenos se necesita un enfoque a nivel microscópico y una solución personalizada específica para la región. Eso es algo en lo que ayudaremos a los agricultores y nutricionistas, junto con otras posibles soluciones para ayudar a resolver el problema.
Hammer?
Jesús: Nosotros nos centramos en soluciones que mejoran la salud intestinal. La mejora proactiva de la integridad intestinal ayuda a evitar que algunos de estos patógenos atraviesen el intestino y tengan un impacto negativo en el rendimiento animal.
Los animales con intestinos más fuertes están mejor capacitados para mantenerse sanos y, si se enferman, pueden recuperarse más rápidamente.
Nuestros productos para la salud intestinal de los productores lecheros, avícolas y porcinos son CELMANAX™ y CERTILLUS™.
CELMANAX™ utiliza Carbohidratos Funcionales Refinados™ para preparar el sistema inmunológico para los retos de las enfermedades, de modo que los animales puedan recuperarse rápidamente. También minimiza la variación en la calidad del alimento para lograr una ingesta constante que ayude a alcanzar los objetivos de producción y peso.
CERTILLUS™ utiliza cepas patentadas de Bacilos para atacar patógenos dañinos específicos de una granja o región. Las pruebas microbianas primero identifican el riesgo de una granja ante ciertos patógenos, incluyendo Clostridium perfringens, E. coli y salmonella; luego, se seleccionan cepas específicas de Bacilos y se utilizan en CERTILLUS™ para ayudar a combatir el reto.
Otros productos disponibles según la región:
DCAD Plus™ repone el potasio utilizado en el mantenimiento diario del ganado lechero y las aves de corral; mantiene a las vacas y las aves hidratadas para combatir mejor el estrés por calor.
BIO-CHLOR™ favorece la ingesta de materia seca en el ganado lechero antes del parto para reducir el tiempo dedicado al diagnóstico de problemas de falta de alimentación posparto.
FERMENTEN™ utiliza proteína metabolizable para favorecer la tasa de crecimiento de las novillas y la producción de leche y componentes de vaca.

Arm & Hammer: Conocimientos globales sobre producción animal aplicados localmente a granjas latinoamericanas DESCARGAR EN PDF
¿Por qué te sientes orgulloso de trabajar para Arm & Hammer?
Guilherme: Ciencia, ética y respeto. Yo sé que nuestros productos funcionan y que los clientes estarán satisfechos con los resultados.
La ciencia está ahí, hacemos las cosas de la manera correcta y nos hemos ganado el respeto de los consumidores, tanto humanos como animales.
Visita el portal de Arm & Hammer en ahfoodchain.com para obtener más información y encontrar a tu representante local.


José Luis Repetto, Cecilia Cajarville Departamento Producción Animal y Salud de Sistemas Productivos – IPAV, Facultad de Veterinaria, UdelaR, San José, Uruguay. (Dirección actual: Departament de Ciència Animal i dels Aliments, Facultat de Veterinària, UAB, Bellaterra, Barcelona)
El grano de sorgo posee varias virtudes para la utilización en rumiantes. Una de sus particularidades es la de ser una gramínea C4, con un mecanismo de absorción del CO2 que le proporciona un mayor rendimiento fotosintético y, por lo tanto, una mayor eficacia en condiciones de calor y sequedad.



Se trata de un cultivo que funciona bien en secano y que es resistente a las plagas, implicando menor uso de insumos. Si se lo compara con el grano de maíz, históricamente ha tenido una relación de precios favorable, siendo además capaz de prosperar en lugares no propicios para el cultivo de éste.
Ante este conjunto de características es de esperar que en condiciones de crisis climáticas como la que vivimos actualmente, el cultivo de sorgo continúe en crecimiento al menos en regiones geográficas donde la falta de agua es un problema cada vez mayor.
En suelos con una profundidad media, las necesidades en agua del sorgo son claramente inferiores a las de otros cultivos de primavera-verano. No sólo es un cereal resistente al cambio climático, sino que además puede contribuir a cuidar un recurso tan valioso como el agua dulce.
Sin embargo, el sorgo tiene características que lo desfavorecen ante otros granos. Hay una heterogeneidad muy grande entre genotipos de grano, con algunos de difícil digestión.
Es así, que desde el punto de vista de su valor nutritivo podemos encontrar materiales que compiten en el aporte de nutrientes con el mejor de los otros granos y otros que ni siquiera podrían ser considerados concentrados de acuerdo con los nutrientes que aportan.
Por otra parte, el aprovechamiento de un grano en particular es difícil de predecir, más allá de estimaciones “a ojo” de acuerdo con el tamaño y color. Es decir, faltan indicadores claros y rápidos para valorar su calidad.

En los próximos párrafos intentaremos explicar por qué sucede esto y cómo podemos superar el cuello de botella de la heterogeneidad en la calidad de granos de sorgo, principal escollo para explotar su capacidad de aportar energía.

Los granos son ampliamente utilizados en las dietas por su aporte energético proveniente del almidón, su principal constituyente. Los almidones son homopolisacáridos, mezcla de moléculas de amilosa y amilopectina.
La amilosa está constituida por cadenas lineales de glucosa unidas por enlaces glucosídicos α (1,4), mientras que la amilopectina es una cadena ramificada, cuyas ramificaciones se unen a una cadena central mediante enlaces α (1,6). Aunque las proporciones que representan la amilosa y la amilopectina son variables de acuerdo con la especie y genotipo del grano, en general la amilosa es minoritaria.
El contenido de almidón y los porcentajes de amilosa y amilopectina dentro de una misma especie puede modificarse genéticamente. En general se acepta que la digestibilidad del almidón está en relación inversa a su contenido en amilosa, que es menos soluble en agua y en otras sustancias, comparada con la amilopectina.
Esta última afirmación es cierta para monogástricos, humanos y rumiantes muy jóvenes, pero es menos importante para rumiantes adultos, en los que otras características del grano cobran más importancia.
En rumiantes adultos, la estructura de la matriz donde se dispone el almidón es determinante tanto de la magnitud como del sitio de digestión de los almidones. Dentro de los granos el almidón está contenido en el endospermo, estructura de reserva que representa entre el 80 y 85% del peso total (Montiel y Elizalde, 2004). A su vez, en el endospermo, el almidón se dispone en forma de gránulos rodeados por una matriz proteica (Figura 1).

matriz proteica gránulos de almidón

Figura 1. Microfotografía del endospermo de sorgo mostrando los gránulos que contienen almidón recubiertos por una matriz proteica (Imagen extraída de Black, 2004)
La matriz proteica del endospermo limita el acceso de las bacterias ruminales a los gránulos y está demostrado que cuanto más organizada es esta estructura, menor es la cantidad y la velocidad con que fermentan los cereales en el rumen (McAllister et al., 1993).

De acuerdo con las características de la matriz podemos diferenciar al menos dos capas en el endospermo de los granos, que se esquematizan en la Figura 2:
Una capa más periférica, en la que la matriz y los gránulos están muy organizados, denominada “endospermo vítreo o córneo”
Una parte central, con mayor concentración de almidón y con una estructura granular más desorganizada, con una matriz proteica discontinua o menos evidente denominada “endospermo harinoso”.

En acuerdo con sus características, el almidón contenido en el endospermo harinoso es mucho más susceptible a la degradación ruminal y a los procesos digestivos en general, así como a la acción de diferentes procesamientos, y una mayor abundancia relativa de este almidón determina que el grano sea más degradable en el rumen y que, por lo tanto, su digestión sea mayoritariamente por fermentación y no por digestión enzimática intestinal (Corona et al., 2006).



El endospermo córneo predomina en granos menos degradables en el rumen como el maíz o el sorgo y el harinoso en granos de rápida degradación como el trigo o la cebada. La relación endospermo córneo/harinoso está regulada genéticamente, aunque algunos factores son capaces de incrementarla, como la maduración del grano y la fertilización nitrogenada (Owens y Zinn, 2005)
En la Figura 3 presentamos la concentración de almidón comparada de diferentes granos de cereales de acuerdo con Humer y Zebeli (2017). Como se observa en la figura, el sorgo es de los granos que contiene más almidón, lo cual no se condice con su baja reputación ni con su menor valor en el mercado.
Trigo
Triticale
Avena
Arroz
Cebada
Sorgo
Maíz
de almidón comparada entre distintos granos de cereales (adaptado de Humer y Zebeli, 2017)
Esta menor reputación se explica en parte por algunas características estructurales y porque, como ya mencionamos, el grano de sorgo se caracteriza por una gran variabilidad en su composición química y tipo de endospermo según el genotipo y también determinada por las condiciones ambientales durante el crecimiento y maduración (Hibberd et al., 1982).
Es así como se pueden encontrar grandes diferencias en el sitio y magnitud de la digestión del grano tanto entre genotipos como dentro de un mismo genotipo (Streeter et al., 1991).
Los granos de sorgo generalmente tienen una capa denominada endospermo periférico, compuesta por las primeras capas de células debajo de la aleurona. Este tejido se caracteriza por ser extremadamente duro, denso y resistente a la entrada de agua.
Los gránulos de almidón que contiene son pequeños y están rodeados de un gran número de cuerpos proteicos compuestos por prolaminas (Montiel y Elizalde, 2004). Esto lo vuelve muy poco disponible para la degradación enzimática, tanto de las enzimas del animal como de los microoganismos del rumen.

Además, algunas variedades de sorgo pueden producir importantes cantidades de taninos, que pueden alcanzar concentraciones de hasta un 7 %, valor muy elevado si se tiene en cuenta que un grano promedio contiene entre 0,1 y 1 % de este tipo de compuesto (Evers et al., 1999)
En la Figura 4 representamos esquemáticamente como es la estructura del endospermo en el grano de sorgo.

Los taninos son metabolitos secundarios de las plantas que cumplen funciones de defensa.
Por ello, los genotipos de sorgo con mayor contenido en taninos poseen ciertas ventajas agronómicas, como una mayor resistencia a la germinación antes de la cosecha, la resistencia a las plagas (insectos, pájaros), o a la contaminación fúngica.
En general el rendimiento del cultivo de sorgos tánicos es alto, con granos sanos, aún en condiciones adversas, y es lo que los hace comunes en algunos mercados.
Químicamente, los taninos son polímeros de compuestos fenólicos que tienen la habilidad de formar complejos indigestibles con las proteínas.
Endospermo periférico
gránulos muy pequeños, rodeados de prolaminas, resistente, más proteína
Endospermo córneo
Endospermo harinoso
TANINOS

4. Esquema de la estructura de un grano de un grano de sorgo
Los taninos del sorgo serían capaces de precipitar proteínas en cantidades 12 veces superiores a su propio peso (Duodu et al., 2003).
Existen dos grandes tipos de taninos: los hidrolizables y los condensados, ambos con capacidad de formar complejos con las proteínas, pero con diferencias.
Cuando los rumiantes consumen taninos hidrolizables, se forman complejos proteína-tanino en el rumen (con un pH cercano a la neutralidad), haciendo indigestibles las proteínas para la población ruminal. Pero este tipo de complejo es dependiente del pH, y en el abomaso se desdoblan dejando libre la proteína para la digestión intestinal.

En otras palabras, transformaron a la proteína del alimento en proteína de pasaje para el rumiante. A través de este mecanismo es que los taninos pueden ejercer efectos beneficiosos en el rumiante, previniendo el timpanismo y aportando proteína de pasaje (Wang et al. 1996).
Sin embargo, cuando se trata de taninos condensados, la unión con las proteínas se produce mediante puentes de hidrógeno. Dicha unión es resistente a pH bajos por lo que los complejos no se desdoblan en el abomaso y terminan dificultando la digestión de las proteínas, que terminan excretándose en las heces.
Dada la estructura granular del endospermo de los granos, tanto la baja degradabilidad ruminal de la proteína que recubre los gránulos como el contenido en taninos, afectan la degradación ruminal del almidón del sorgo. De hecho, parece haber una estrecha relación entre el contenido en taninos del sorgo y la degradabilidad de materia seca, la proteína y el almidón del grano, como puede apreciarse en la Figura 5.
La interacción entre proteínas y taninos no solo modifica la digestibilidad del grano, sino que también afecta su palatabilidad. La astringencia es la sensación causada por la unión de taninos y glicoproteína salivar, llevando a un aumento en la salivación y menor aceptabilidad (Besharati et al., 2022).
¿QUÉ
Este va a ser el tema central de la parte II de esta entrega, aunque aquí realizaremos algunos comentarios a modo de introducción. Primero que nada, debemos saber que hay varias cosas que podemos hacer para mejorar el aprovechamiento del sorgo por los rumiantes. Como siempre, todo tratamiento que realicemos trae asociado un costo, que tendremos que considerar cuando tomemos la decisión de su empleo.
Figura 5. Degradación ruminal de la materia seca (DMS), del almidón (Dalmidón) y de la proteína (DPB) de diferentes híbridos de sorgo (16 h de incubación en el rumen), según Montiel et al. (2011).

Tratar el grano de sorgo resulta imprescindible ya que se trata de un grano que, a las dificultades que presenta para su digestión, se suma el pequeño tamaño. Esto hace que al menos, debamos molerlo antes de su suministro.
Otro aspecto a tener en cuenta es que, cuando se trata mejorar el aprovechamiento digestivo de un grano para los rumiantes, el partido se juega en el rumen. En general es cierto que el almidón (y por lo tanto los granos) que se aprovechan poco en el rumen, tienen una segunda oportunidad en el intestino, ya que el rumiante tiene amilasas a este nivel.
Sin embargo, cuando se trata de un grano de difícil digestión como es el sorgo, la digestión intestinal no alcanza para compensar una pobre degradación en el rumen. Por ello, si no hacemos lo posible por aumentar la fermentación (y degradación) del grano en rumen, el resultado será una baja digestibilidad global.
Por último, a modo de adelanto de la próxima entrega sobre el tema, presentamos gráficamente en la Figura 6 los tratamientos que han sido más ensayados en el grano de sorgo y su capacidad para mejorar la degradación/fermentación en rumen.
Por supuesto que la posibilidad de tratar un grano depende de varios factores (infraestructura, equipamiento disponible en las cercanías, etc.), pero veremos que no necesariamente tendremos que recurrir a los tratamientos más costosos, que implican vapor y presión (como el extrusado), para lograr buenos resultados.
Tratamientos como el reconstituido (que consiste en remojar el grano cosechado seco y luego ensilarlo), o el grano húmedo (que consiste en cosechar el grano de la parcela cuando todavía tiene 25% de humedad o más y luego ensilarlo), pueden ser tan o más efectivos para alimentar rumiantes que los procesos que involucran más maquinaria o energía y que deben realizarse en plantas especializadas.
Referencias disponibles en la versión web del artículo en nutrinews.com
El sorgo, un grano que prospera en tiempos de cambio climático (Parte I) DESCÁRGALO EN PDF
Figura 6. Tratamientos posibles para aumentar la degradación del sorgo en el rumen y favorecer a ese nivel la fermentación del almidón
S.A.

Definición
Aunque existen diferentes formas matemáticas de estimar la eficiencia alimenticia, la ingesta de alimento residual (RFI) es hoy en día la más utilizada.
Propuesto por primera vez en bovinos por Koch et al. (1963), RFI, es como ya vimos, la diferencia entre la ingesta real de alimento de un animal y su ingesta de alimento prevista en función de su rendimiento, medido durante un período de tiempo fijo.
La ingesta prevista es la necesaria para cubrir las demandas de los diferentes sitios de gasto energético (producción de leche, crecimiento, mantenimiento, etc.), estimados por regresión.


Una de las principales ventajas es, en contraste con rasgos de proporción como la tasa de conversión alimenticia, es la ausencia de correlación entre el rasgo de eficiencia y sus predictores como la producción de leche o el peso corporal (clásicamente a nivel fenotípico, pero también propuesta a nivel genético por Kennedy et al., 1993).

Esto es particularmente interesante para fines de selección genética (Berry y Crowley, 2013). Sin embargo, persisten algunos problemas con este enfoque.
El primer problema está relacionado con el uso de coeficientes lineales estáticos en la ecuación de regresión. Cuando se aplica a animales lactantes, esto no refleja la realidad biológica de los diferentes procesos que ocurren en diferentes etapas de la lactancia, como la movilización de la reserva corporal en la lactancia temprana o la acumulación de reservas asociada con la preñez en la lactancia tardía.
Por lo tanto, la estimación de RFI durante toda la lactancia con una regresión lineal conduce a evaluaciones sesgadas (Li et al., 2017).
Varios estudios han explorado más a fondo la metodología de RFI o las relaciones entre sus componentes (por ejemplo, Manzanilla Pech et al., 2014; Strathe et al., 2014; Lu et al., 2015) que condujeron recientemente al desarrollo de nuevos métodos basados en modelos de regresión aleatoria multi rasgo que incorporan la dimensión dinámica de los datos y proponen una solución a este primer problema (Islam et al., 2020; Martin et al., 2021b).
Sin embargo, como el número de parámetros a estimar en el modelo es considerablemente mayor que para una regresión lineal clásica, el número de registros requeridos para su estimación es mayor, lo que lleva a un segundo problema.
Los conjuntos de datos de ingesta de alimento residual tienden a ser relativamente pequeños debido a la dificultad y el costo de medir la ingesta.
Por lo tanto, el fenotipado a gran escala (con el fin de proporcionar una población de referencia para la selección genómica, por ejemplo) requiere la agrupación de datos en diferentes granjas y años. Sin embargo, la agrupación entre sitios y años implica fusionar animales con diferentes dietas que tienen su propio contenido energético.

Además, si se utiliza la ingesta de MS como medida, la estimación de la eficiencia se contamina por las diferentes densidades de energía de alimentación. El uso de una conversión a la ingesta de energía basada en los valores contables también podría introducir sesgos y potencialmente reducir cualquier variación en la eficiencia digestiva (Martin et al., 2021a).
En el Cuadro 1 se pueden ver vías metabólicas que subyacen al consumo de alimento residual en terneros Charoláis de engorde.
a. Medidas de consumo de nutrientes (1)
b. Estimación de nutrientes ingeridos y absorbidos
Presencia neta en el sistema porta (mmol/h kg BW (2)
a, b: Medidas comparadas sólo con la misma dieta. Diferentes letras significan diferencia significativa de acuerdo a Tukey test (p,05). 1: Medidas basadas en ingestión de materia seca. 2: Estimado de acuerdo con Loncke et al.
Cuadro 1. Vías metabólicas comunes y específicas de la dieta que subyacen al consumo de alimento residual en toros Charolais de un año de engorde. https://www.researchgate.net/publication/357240256_Common_and_diet-specific_metabolic_pathways_ underlying_residual_feed_intake_in
La literatura nos ofrece ideas sobre cómo intentar solucionar este problema. Por ejemplo, Tempelman et al. (2015) y Lu et al. (2017) utilizaron regresiones aleatorias específicas de la ración, de la ingesta de materia seca basados en la energía de la leche y el peso corporal.
Sin embargo, toda la información necesaria sobre la dieta de las vacas no siempre está disponible.
Por lo tanto, es útil buscar métodos más simples que puedan usarse al menos dentro de tipos amplios de alimentación en granjas, especialmente cuando se usan metodologías como Martin et al. (2021b) también aborda el primer problema.


Dejar que el comedero se vacíe no es la solución para reducir los costos de alimentación. Cuando la alimentación está restringida, el pH ruminal puede llegar a ser muy alto (alcalino). Un pH alto inhibe las bacterias que usan el lactato, dejando un ecosistema ruminal susceptible a la acidosis.
En esos momentos, el equilibrio microbiano se rompe y el ganado tiende a comer en exceso cuando se vuelve a ofrecer alimento, lo que aumenta su riesgo de acidosis al comer la siguiente comida abundante.

Es normal recomendar que los rechazos para el grupo de recién paridas sean de alrededor del 2 al 4%, del 1 al 3% para los grupos de alta producción y del 0,5 al 3% para los grupos de lactancia tardía.
Cuanto más diferentes en apariencia y tamaño de partícula son los rechazos del alimento ofrecido, más rechazos deben dejarse para estar seguros, que había alimento de “calidad” disponible si las vacas querían más.

De este tema hay pocas publicaciones científicas concluyentes y muchas recomendaciones sobre las tasas

Controlar el consumo residual de alimentos es mantener el equilibrio (Parte II) DESCÁRGALO EN PDF
Ingrid Caroline da Silva1, Karla Gabriela Memare1 y Bruna Aparecida Moreira da Silva2
1Estudiante de Doctorado en Producción Animal - PPZ UEM
2Estudiante de Licenciatura en Zootecnia - UEM

Para que un alimento sea considerado completo y balanceado, debe contener todos los nutrientes esenciales para satisfacer las demandas nutricionales específicas de cada especie.
Los alimentos se formulan con ingredientes que proporcionan todos los nutrientes necesarios, dividiéndose en grupos:
Los macronutrientes incluyen proteínas, carbohidratos, grasas y bras;
Los micronutrientes están representados por los minerales y vitaminas.
Además, un alimento puede contener en su formulación ingredientes con propiedades funcionales, proporcionando beneficios extras a los animales.
Desde el punto de vista nutricional, los minerales son elementos inorgánicos esenciales para el desarrollo y mantenimiento del organismo.
Pueden clasificarse según su papel biológico y/o contenido presente en los tejidos animales, siendo responsables de ejercer diversas funciones importantes para el organismo, como:

Los macroelementos incluyen Calcio, Fósforo, Potasio, Magnesio, Sodio, Cloro y Azufre, mientras que los microelementos están compuestos por Hierro, Cobre, Cobalto, Yodo, Manganeso, Zinc, Selenio, Molibdeno y Flúor.
La manutención y regulación de los tejidos corporales;
Actuación en los sistemas musculoesquelético, enzimático y endocrino;
Contribución a la digestión y absorción de nutrientes;
Además del mantenimiento del sistema nervioso central.
Estos minerales pueden encontrarse en diversos alimentos, tanto de origen animal como vegetal, y cada uno desempeña una función específica contribuyendo al equilibrio del organismo.
De acuerdo con la necesidad, los minerales se dividen en macroelementos y microelementos. Los macroelementos son requeridos por el organismo animal en mayor cantidad, mientras que los microelementos son necesarios en menor cantidad.
En el contexto de la comida para mascotas, es crucial considerar la calidad y las fuentes de los minerales para determinar la cantidad disponible para absorción y utilización, es decir, su biodisponibilidad.
Además, es importante tener en cuenta los efectos de los minerales durante el proceso de fabricación del alimento, como en el caso de la extrusión.
La biodisponibilidad de los minerales se refiere a la cantidad de un mineral presente en una forma química específica que está disponible para la absorción y utilización por el organismo.
Este proceso está influenciado por diversos factores, incluyendo la tasa de absorción intestinal, que depende de elementos como el contenido del mineral, la matriz alimentaria, la interacción con otros nutrientes, la forma química y el procesamiento.
Existen divergencias en cuanto al grado de disponibilidad de minerales en las formas orgánicas e inorgánicas, especialmente en el caso de minerales traza como Mercurio, Plomo, Cadmio y Arsénico.

influenciada por el mineral en cuestión, las condiciones dietéticas y el estado fisiológico del animal.
Las fuentes de minerales más comúnmente utilizadas en la nutrición animal son en forma inorgánica, incluyendo óxidos, sulfatos, cloruros, carbonatos y fosfatos.
En los sitios de absorción en el tracto digestivo, ocurren competencias en las cuales los macro y microelementos están sujetos (Figura 1)
Absorción de minerales inorgánicos
Los minerales de la fuente inorgánica compiten con los aminoácidos, lo que provoca una absorción de ciente de minerales y pérdida de nutrientes en las heces.
Minerales inorgánicos
Aminoácido
Absorción de minerales orgánicos
La quelación de minerales y aminoácidos da lugar a una mayor absorción.
Figura 1. Absorción intestinal de minerales inorgánicos y orgánicos
Minerales quelatados
Las investigaciones indican que la biodisponibilidad de los minerales puede mejorarse cuando están ligados a moléculas orgánicas, como aminoácidos o péptidos, resultando en lo que se denomina minerales orgánicos o quelatados.
Los minerales quelatados han sido ampliamente estudiados debido a su mayor biodisponibilidad en comparación con las fuentes inorgánicas.
En un estudio realizado por França et al. (2008), al probar diferentes fuentes de zinc para gatos adultos, se observó que la fuente de zinc orgánico presentó una mayor deposición en el pelaje en comparación con la fuente inorgánica de óxido de zinc.
El procesamiento de ingredientes o del alimento también puede afectar la biodisponibilidad de los minerales.

Las fuentes orgánicas de minerales no solo proporcionan una mejor absorción, sino que también exhiben efectos beneficiosos durante la vida útil de la comida para mascotas, retardando el proceso oxidativo de los alimentos.
Este fenómeno fue evidenciado en un estudio realizado por Silva (2021), en el cual se probaron diferentes fuentes (inorgánica vs. orgánica) y niveles (1x y 2x la recomendación de FEDIAF, 2021) de minerales.
Un tratamiento térmico excesivo puede reducir la biodisponibilidad de ciertos minerales, y la interacción con otros ingredientes en la formulación puede interferir en la absorción de minerales.
Además, el equilibrio entre diferentes minerales en la dieta también influye en su biodisponibilidad, ya que el exceso de un mineral puede inhibir la absorción de otro.

Durante los 12 meses de vida útil en el estante, los alimentos para mascotas suplementados con la fuente inorgánica presentaron 8,413 mEq/100g de peróxido, mientras que la fuente orgánica registró 4,816 mEq/100g de peróxido (Figura 2).
Este índice refleja los productos primarios de la oxidación lipídica, lo que indica que el uso de fuentes orgánicas puede prevenir la oxidación lipídica durante la vida útil en el estante.
Los autores también observaron, a los 360 días, una tendencia a la reducción de los ácidos grasos (Figura 3), con una menor retención cuando se utilizó la fuente inorgánica 2 veces la recomendación (74,4%).
Las pérdidas fueron más pronunciadas en los ácidos grasos poliinsaturados debido a su estructura lipídica más susceptible a la oxidación.
Figura 2. Curvas del índice de peróxidos durante la vida útil de 360 días en las dietas Control (CD), Minerales Inorgánicos (MI-1 y MI-2) o Minerales Orgánicos (MO-1 y MO-2).

Además, la retención de antioxidantes después de 360 días de vida útil en el estante varió del 29,8% al 42,3%, con una tendencia al efecto del tratamiento, mostrando una mayor retención cuando los minerales se suministraron en forma orgánica 2 veces la recomendación.
Los antioxidantes desempeñan un papel crucial en la protección de los ácidos grasos durante la extrusión y en su conservación a lo largo de la vida útil en el estante.
Retención de antioxidantes Ácidos grasos poliinsaturados
Figura 3. Retención total de ácidos grasos poliinsaturados y antioxidantes sintéticos BHA y BHT tras 360 días de conservación en las dietas Control (DC), Minerales Inorgánicos (MI-1 y MI-2) y Minerales Orgánicos (MO-1 y MO-2).
De esta manera, los autores concluyeron que los niveles y fuentes de los microminerales no impactan significativamente en la estabilidad oxidativa de la ración durante el procesamiento, sino a lo largo de la vida útil en el estante.
Notablemente, las fuentes orgánicas en forma de proteinatos, en comparación con la suplementación de hierro, cobre y zinc en forma de sulfato, contribuyeron a una mayor estabilidad oxidativa del alimento.
En resumen, al formular una dieta, es crucial buscar fuentes de buena calidad para garantizar una mejor biodisponibilidad.
Además, es importante proporcionar los minerales en formas y cantidades de fácil absorción, teniendo en cuenta las variables del proceso para minimizar los efectos adversos durante la fabricación y la vida útil en el estante del alimento para mascotas.
Minerales en el alimento de perros y gatos: efectos de la extrusión y vida útil DESCARGAR PDF
Referencias bibliográficas bajo petición.
